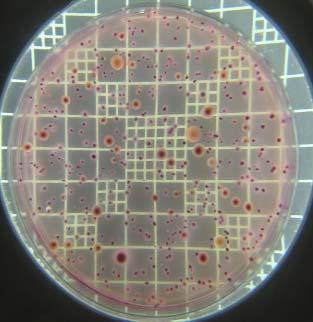

Temas Selectos de Ingeniería de Alimentos

Volumen 5 / No. 1
Ene –Mayo 2011
DIRECTORIO
TEMAS SELECTOS DE INGENIERÍA DE ALIMENTOS
UNIVERSIDAD DE LAS AMÉRICAS PUEBLA
PUBLICACIÓN SEMESTRAL
VOLUMEN 5, NÚMERO 1 (ENERO - MAYO 2011)
EDITORA RESPONSABLE
María Eugenia Bárcenas Pozos
CONSEJO EDITORIAL
Aída Irma Gómez Sánchez
María Teresa Jiménez Munguía
Emma Mani López
María Elena Sosa Morales
Fidel Tomás Vergara Balderas
CERTIFICADO DE RESERVA DE DERECHOS:
04-2010-080615025900-102
CERTIFICADO DE LICITUD DE TÍTULO Y CONTENIDO: 15430
DOMICILIO:

Fundación Universidad de las Américas Puebla
Exhacienda Santa Catarina Mártir S/N
San Andrés Cholula, Pue.
C.P. 72810 México
Teléfono: 222 229 2126
DISTRIBUIDO POR:
Departamento de Ingeniería Química, Alimentos y Ambiental
Fundación Universidad de las Américas Puebla
IMPRESIÓN:
Gutiérrez Mora Carina
18 Sur 6130 Local A. Col. Jardines San Manuel
Puebla, Pue. C.P. 72570

Temas Selectos de Ingeniería de Alimentos Vol. 5 / No. 1

Cuerpo
editorial
Dra. María Eugenia Bárcenas Pozos
Dra. María Teresa Jiménez Munguía
M. C. Emma Mani López
M. C. Fidel Vergara Balderas

Contenido
Temas Selectos de Ingeniería de Alimentos Vol. 5 / No. 1

Volumen 5 / No. 1 Ene - Mayo 2011
Cuerpo editorial …………………………………………………………………………………. i Carta editorial …………………………………………………………………………………….. iii
Artículos de Revisión
Cambios en características funcionales de productos alimenticios tratados por homogeneización a ultra alta presión
G. G. Amador Espejo* y H. Ruiz-Espinosa …..……………...………………………...……..... 1
Nanotecnología en alimentos
G. Soto-Chilaca* y A. López-Malo ………………...…..………...……………………………. 11
Procesos avanzados de oxidación y su aplicación en alimentos
V. Aurioles-López*, A. López-Malo y E. R. Bandala ………………………….……...…….... 22
Mostaza: características químicas, botánicas y sus aplicaciones en el área de alimentos
B. Mejía-Garibay*, A. López-Malo y J.A. Guerrero-Beltrán ………………………………... 32
Actividad antimicrobiana de aceite esencial de tomillo (Thymus vulgaris)
A. Rosas-Gallo* y A. López-Malo ………………………………………………………...…..... 41
Extractos de vainilla: una mezcla de componentes químicos de aroma y sabor
T.S. Cid-Pérez* y A. López-Malo …………………………………………….………………. 51

Editorial
Temas Selectos de Ingeniería de Alimentos Vol. 5 / No. 1

En este número de la revista Temas Selectos de Ingeniería de Alimentos se publican artículos de revisión sobre los temas de tesis abordados por los estudiantes del posgrado en Ciencia de Alimentos de la Universidad de las Américas Puebla. Las contribuciones de este número dan una visión de los fundamentos, avances y puntos de vista de las temáticas actuales en Ciencia de Alimentos para quienes se introducen en un nuevo tema y quieren conocer los puntos de vista sobre diversas temáticas. El reto de buscar, analizar, organizar y presentar la información publicada de forma coherente y comprensible se cumple, estos trabajos muestran el trabajo conjunto de estudiantes, asesores y editores.
En el departamento de Ingeniería Química, Alimentos y Ambiental estamos comprometidos con la formación de nuestros estudiantes de posgrado en Ciencia de Alimentos, estos esfuerzos incluyen los trabajos de los estudiantes para divulgarlos como parte importante de difusión del conocimiento en las distintas áreas de investigación relacionadas con Alimentos que permiten desarrollar en los estudiantes la habilidad de la escritura y facilitan el acceso de estos conocimientos a la comunidad universitaria.
Aprovecho este espacio para agradecer a los colegas profesores e investigadores que dedican gran parte de su tiempo en la asesoría de nuestros estudiantes en su formación como nuevos investigadores, así como al cuerpo editorial por su dedicación y entusiasmo en la edición y publicación de este número de la revista. La calidad de los artículos que se publican en Temas Selectos de Ingeniería de Alimentos refleja la entrega de todos.
Aurelio López-Malo
Profesor Departamento de Ingeniería Química, Alimentos y Ambiental Universidad de las Américas Puebla

Temas Selectos de Ingeniería de Alimentos 5-1 (2011): 1-10

Cambios en características funcionales de productos alimenticios tratados por homogeneización a ultra alta presión
G. G. Amador-Espejo*, H. Ruiz-Espinosa1
*Departamento de Ingeniería Química, Alimentos y Ambiental, Fundación Universidad de las Américas Puebla. Exhacienda Sta. Catarina Mártir S/N, Cholula, Puebla. C.P.72810. México. 1Facultad de Ingeniería Química. Benemérita Universidad Autónoma de Puebla. Puebla, México.
Resumen
En los últimos años la homogeneización a ultra alta presión (HUAP) ha sido empleada como método de conservación en alimentos. Además de obtener un nivel de inactivación similar al obtenido por tratamientos térmicos, debido a fenómenos de cavitación, impactos a alta velocidad, cizalla y elevación de temperatura (por corto tiempo), la aplicación de HUAP puede modificar la microestructura de los productos presurizados. Además se ha reportado que es capaz de provocar otros cambios fisicoquímicos relevantes. Dentro de los cambios detectados se encuentran disminución de viscosidad, modificación del comportamiento reológico, reducción en el tamaño de partícula, inactivación enzimática, incremento en la capacidad de retención de agua, mayor firmeza en geles, reducción del tiempo de coagulación, prevención de la degradación de fenoles y otros compuestos con actividad antioxidante, entre otros. Todo ello lleva a considerar a la HUAP como una tecnología viable para generar productos con propiedades funcionales únicas. El propósito de esta revisión es presentar un panorama general de los trabajos publicados a la fecha sobre los cambios estructurales físicos y químicos en diversos productos sujetos a HUAP y los cambios en propiedades funcionales atribuibles a este tratamiento.
Palabras clave: homogeneización a ultra alta presión, propiedades funcionales, tecnologías no térmicas.
Abstract
During the last few years, a process known as ultra-high pressure homogenization (UHPH) has been employed as a novel food preservation method. Cavitation, high-speed impacts, shear stress and adiabatic heating have been considered the main preservation mechanisms. Besides obtaining an inactivation level similar to that of heat treatment, UHPH is capable of modifying the food structure and carrying out significant chemical and physical changes to the pressurized food matrix. Several modifications have been detected including viscosity reduction, rheological behavior modification, particle size changes, enzyme inactivation, an increased water holding capacity, firmer gels, coagulation time reduction, reduced loss of antioxidant activity, among others. Therefore, UHPH can be considered a valuable alternative to obtain products with unique functional characteristics. The main purpose of this review is to present an up-todate general overview of published results regarding structural, physical and chemical changes in selected UHPH food products and changes in their functional properties attributable to this process.
Keywords: High pressure homogenization, functional properties, non-thermal technologies.
*Programa de Doctorado en Ciencia de Alimentos
Tel.: +52 222 229 2126, fax: +52 222 229 2727
Dirección electrónica: genaro.amadoreo@udlap.mx
Introducción
La acrilamida (CH2=CH–CONH2) es un monómero utilizado a nivel industrial desde los años 50’s, está presente en el humo del tabaco, y es usado en la síntesis de poliacrilamida para su utilización en procesos como purificación de agua, separación de proteínas para bioquímica analítica y acondicionamiento de suelos (Allan, 2002). Su descubrimiento se origina a partir de resultados de la formación de un aducto específico entre ésta y la hemoglobina humana (Masson et al., 2007).
Es un compuesto muy reactivo y se ha estudiado por los daños que puede provocar luego de exposiciones prolongadas. Al estudiar acerca de la presencia de acrilamida en la sangre, y encontrarla en personas que nunca habían estado expuestas directamente, Tareke et al. (2002) evaluaron diferentes alimentos, encontrando niveles desde moderados a altos de este compuesto en algunos de ellos. De esta manera, surgió el interés por evaluar la acrilamida en los alimentos, así como su origen y los daños que su ingesta puede ocasionar en el organismo humano.
Diversos estudios comprobaron la presencia de acrilamida en alimentos, particularmente en aquellos con alto contenido de carbohidratos (El-Ziney et al., 2009). Posteriormente los estudios fueron encaminados hacia los mecanismos mediante los cuales pudiera ocurrir la formación de acrilamida, conociéndose actualmente que el mecanismo más probable es mediante la reacción de Maillard, particularmente la que ocurre entre la glucosa y la asparagina (Mottran et al., 2002; Stadler et al,. 2002). Una vez conocidos sus mecanismos de formación, el énfasis ha estado en encontrar métodos o ingredientes que permiten la disminución del contenido final de acrilamida en alimentos, desde la modificación en las materias primas, hasta su
inactivación y eliminación una vez que ha sido formada. Sin embargo, muchos de ellos no son muy recomendables ya que modifican las características de calidad y sensoriales de los productos (Anese et al., 2009).
Así mismo, debido a que se conoce que la exposición prolongada a la acrilamida a través de la piel puede provocar daños desde entumecimientos hasta carcinogénesis, diversos estudios han evaluado los riesgos que conlleva la ingesta de acrilamida a través de los alimentos, realizando pruebas en animales y analizando a pacientes con cáncer, para determinar si la acrilamida fue un factor de riesgo (Friedman, 2003).
Esta revisión pretende dar un panorama general del conocimiento actual respecto a la acrilamida, resumiendo sus características generales, enumerando los alimentos que la contienen en mayor concentración, presentando los métodos más comunes y más confiables para su detección, y los estudios que han buscado determinar su riesgo a la salud, y finalmente presentando los métodos que permiten la reducción del contenido final de acrilamida.
Revisión Bibliográfica
1. Aspectos generales de la acrilamida
La acrilamida (2-propanamida) es un compuesto altamente soluble en agua y su peso molecular es bajo (71.09 g/mol). Es un monómero vinílico que se usa tanto a nivel industrial como en procesos de laboratorio. Su uso más importante es la producción de poliacrilamida de alto peso molecular, utilizada para proporcionar a los materiales propiedades iónicas (El-Ziney et al., 2009). Algunas de las aplicaciones más comunes de esos polímeros son: tratamiento de agua para beber, procesamiento de petróleo, papel,
minerales, concreto y textiles, en la industria de los cosméticos, en cirugías oftálmicas, en plásticos, en lentes de contacto, y en emulsiones y adhesivos, además de estar presente en el humo del tabaco (Sharma et al., 2008).
A nivel comercial se produce por hidrólisis catalítica del acrilonitrilo. Puede encontrarse tanto en estado sólido o cristalino, como líquido o acuoso. El monómero sólido es incoloro y es un cristal soluble en agua, metanol, etanol, acetona y dimetil éter, e insoluble en benceno y heptano (Sharma et al., 2008).
La acrilamida es absorbida por los animales y los seres humanos, vía ingestión, inhalación o a través de la piel. Tiene dos sitios reactivos, el grupo amida y el doble enlace conjugado, éste último puede participar en reacciones nucleofílicas con grupos funcionales que tengan hidrógeno activo como los grupos SH de la cisteína, homocisteína y el glutatión, o los radicales R-NH2 de aminoácidos libres y proteínas. La exposición de la acrilamida a pH muy alto o bajo provoca su hidrólisis a ácido acrílico y amoniaco (Friedman, 2003).
2. Acrilamida en alimentos
Desde el 2002 se ha demostrado que la acrilamida se forma en algunos alimentos, especialmente aquellos que involucran durante su procesamiento el uso de altas temperaturas como el freído, horneado o secado (El-Ziney et al., 2009). Tomando en cuenta que entre mayor concentración de acrilamida por cada kg de peso corporal se tiene un mayor riesgo, los niños están en mayor peligro que los adultos. En el caso de los bebés, Sorgel et al. (2002) encontraron que de 10 a 50% de la acrilamida consumida en la dieta de las mujeres embarazadas, es transferida vía sangre a los fetos, además de transferirse a través de la leche materna. Por tanto, se recomienda a mujeres embarazadas no consumir o reducir el
consumo de alimentos con alto contenido de acrilamida.
2.1. Formación de acrilamida en alimentos
Desde que se detectó la presencia de acrilamida en alimentos, ha sido sumamente estudiado su mecanismo de formación. Entre las hipótesis de su formación, la reacción de Maillard de pardeamiento, que involucra la reacción a altas temperaturas entre los aminoácidos libres (especialmente la asparagina) y azúcares reductores como la glucosa o fructosa, ha sido de las más estudiadas (Mottran et al., 2002; Stadler et al., 2002). Además es necesario considerar que otros aminoácidos que producen bajas cantidades de acrilamida son: alanina, arginina, ácido aspártico, cisteína, glutamina, metionina, treonina y valina (Masson et al., 2007).
La reacción de Maillard se ilustra mediante las Fig. 1 y 2, donde se aprecia la reacción entre la asparagina y un azúcar reductor mediante dos mecanismos, el primero (1) con la transformación de la asparagina y el azúcar a una base de Schiff descarboxilada, que posteriormente es transformada a acrilamida con 3-aminopropionamida como intermediario; mientras que en el mecanismo 2, el flujo de electrones lleva directamente a la acrilamida sin la formación del intermediario 3-aminopropionamida (Friedman y Levin, 2008).
Además del mecanismo anterior, se ha investigado el mecanismo de formación de acrilamida a partir de lípidos (Ehling et al., 2005), identificando al ácido acrílico como un precursor potencial. Esta teoría ha provocado estudios sobre la influencia del aceite de freído en el contenido final de acrilamida, pues se ha observado que la acroleína (formada por la rancidez oxidativa) puede reaccionar por oxidación para dar ácido acrílico, o formar un radical acrílico intermedio, ambos compuestos

Mecanismo deformacióndeacrilamida(AdaptadadeFriedmanyLevin,2008)

2. Mecanismo de formación de acrilamida directamente mediante el flujo de electrones (Adaptada de Friedman y Levin, 2008).
en presencia de nitrógeno y bajo condiciones de reacción favorables, pueden dar lugar a la formación de acrilamida (Taeymans et al., 2004). Dicha formación puede ocurrir cuando la acroleína (producto de la oxidación de los ácidos grasos) es directamente transformada a acrilamida por una reacción con NH3 para luego oxidarse a acrilamida, o la acroleína puede reaccionar con asparagina directamente y formar un N-glicósido, que posteriormente se transforma a acrilamida (Friedman, 2003).
Por su parte, en su estudio acerca del mecanismo de formación de acrilamida en alimentos, Zyzak et al. (2003) evaluaron diferentes compuestos carbonílicos (Dglucosa, 2-desoxiglucosa, ribosa y gliceraldehído) para observar la reacción con asparagina y el mecanismo de formación de acrilamida, confirmando mediante la presencia de espectrometría de masas, la presencia de los intermediarios de la reacción.
Fig.
Fig.1
2.2. Métodos de análisis
Debido a la alta solubilidad y reactividad y la carencia de un grupo cromóforo, la acrilamida no es fácilmente detectable (Mottran et al., 2002). Sin embargo, existen diversos métodos utilizados para su detección, inicialmente para agua, fluidos biológicos, y alimentos no cocinados, la mayoría de ellos basados en cromatografía líquida de alta resolución (HPLC) o cromatografía de gases. Sin embargo, debido a la complejidad de los sistemas alimenticios, ha sido necesario ir desarrollando otros métodos con alta sensibilidad. Los métodos posteriores se enfocaron en una combinación de cromatografía líquida o cromatografía de gases, con espectrometría de masas (LC-MS, o GC-MS, respectivamente, por sus nombres en Inglés) (Taeymans et al., 2004; Tareke et al., 2002). La ventaja de los métodos basados en LC-MS es que la acrilamida puede analizarse sin necesidad de realizar una derivatización previa, simplificando el análisis (Masson et al., 2007). Otro método es la Reacción de Transferencia de Protones seguida de espectometría de masas (PTR-MS), el cual es un método conveniente por sus rápidas mediciones (Masson et al., 2007).
Los estudios realizados han mostrado que la extracción incompleta es la causa más probable de error en la determinación de acrilamida, ya sea porque el alimento no se dividió correctamente, se usaron solventes orgánicos en la extracción, o el tiempo es corto y la temperatura baja durante la extracción. Otra causa de error ha sido la destrucción de la acrilamida durante la extracción. Por tanto, un reto existente es el desarrollo de métodos confiables y aplicables a diferentes sistemas, que permitan el análisis de alimentos complejos, ya que actualmente los métodos han mostrado gran variabilidad de una muestra a otra y no existe un método confiable y con alto umbral de detección aplicable a todos los
alimentos (Taeymans et al., 2004). Además, su análisis se complica debido a que la acrilamida es una sustancia reactiva y volátil que puede autodegradarse luego de su formación (Masson et al., 2007).
2.3. Alimentos con mayor contenido de acrilamida
Como se ha expuesto, la presencia de acrilamida en alimentos se ha observado principalmente en aquellos ricos tanto en glucosa como en asparagina, y que son sometidos a procesos de calentamiento como horneado o freído. La mayoría de esos alimentos son derivados de origen vegetal como las papas y cereales. Entre estos alimentos, los que han presentado niveles más altos son: las papas a la francesa, papas y tortillas fritas, corteza de pan, y pan tostado, entre otros.
El-Ziney et al. (2009) evaluaron diferentes alimentos de Arabia Saudita con alto contenido de carbohidratos expuestos durante su proceso de elaboración a altas temperaturas. Dichos alimentos los clasificaron en grupos dependiendo de sus características: papas fritas, maíz y extruidos, berenjenas, panes, bizcochos, galletas, pescados, dulces y caramelos, fórmulas infantiles, y fórmulas infantiles en polvo adicionadas con frutas o cereales. Los resultados obtenidos se muestran en la Tabla I junto con alimentos y su contenido reportado de acrilamida.
Sin embargo, la información reportada debe tomarse con precaución, ya que el contenido de acrilamida puede ser muy variable incluso con el mismo alimento producido en diferentes lugares, o entre productos de la misma marca, ya que depende en gran medida de la cantidad de precursores iniciales, y del proceso mediante el cual fue realizado (Friedman y Levin, 2008).
Tabla I. Niveles de acrilamida en algunos alimentos y bebidas.
GrupoAlimento
Palomitas de maíz
Totopos
Maíz
Papas
Pan
Extruidos con sal
Niveles de acrilamida (µg/kg)
180 b
199 b
272 a
Tortillas (de harina y maíz) 6 b
Papas fritas
466 b
Papas a la francesa 206a ; 413b
Pan tostado
Pan integral
Bagels
Donas con levadura
Hot cakes y waffles
Pan blanco
Café
Galletas
213 b
39 b
31 b
18 b
15 b
11 b
Pastel 10 b
Café soluble variedad Robusta
Café tostado variedad Arábica
Café de grano
Integrales
Con chispas de chocolate
Con miel
Chile con carne
Pescado a la parrilla
Cárnicos
Semillas
Cereales listos para comer
Otros
820 a
290 a
7 b
458 b
130 b
50 a
130 b
35 a Nuggets de pollo
Pescado frito
Almendras (fritas o tostadas)
24 b
17 a
320 b
Cacahuates tostados 27 b
Cereal de avena
Hojuelas de maíz
174 b
61 b
Arroz inflado 56 b
Granola 51 b
Pizza
20 b
Fórmulas para bebés 10-30 a
a El-Ziney et al. (2009); b Friedman y Levin (2008).
2.4. Métodos para disminuir su formación
Con el creciente interés en el contenido de acrilamida en alimentos, se han realizado diversos estudios con el propósito de plantear alternativas que permitan su reducción. Para lograrlo, se han tomado diferentes enfoques,
desde reducir la concentración de los precursores, hasta eliminar la acrilamida ya formada. Es por esto que a continuación se mencionan algunos de los enfoques, así como estudios realizados en este respecto, y sus resultados.
a) Reducción en la concentración de los precursores.
Una disminución en el contenido de asparagina puede darse de varias maneras, una es seleccionar de los vegetales disponibles y sus variedades aquellos con el menor contenido de este aminoácido, ya que al estudiar la formación de acrilamida en productos derivados de cereales, se ha observado que mientras más alto es el contenido de asparagina inicial en el trigo, mayor es la concentración de acrilamida en el producto final. Se han evaluado los factores que propician la alta concentración de este aminoácido, encontrando por ejemplo que el trigo cultivado en suelos con bajos niveles de sulfatos tiene hasta 30 veces más asparagina que el cultivado en suelos regulares (Friedman y Levin, 2008). Lo mismo ocurre con las papas, donde la variedad y el suelo de cultivo generan diversas cantidades de carbohidratos y de asparagina, por lo que es necesario seleccionar la variedad con menor cantidad de esos azúcares reductores (Taeymans et al., 2004).
Otro método para disminuir el contenido de asparagina sería inducir su hidrólisis a ácido aspártico y amoniaco mediante bajos pH y/o catalizada por asparaginasa, y finalmente otra opción sería acetilar la asparagina a Nacetilasparagina, previniendo de esta manera la formación de intermediarios N-glicosídicos que forman la acrilamida. También debe cuidarse la temperatura de almacenamiento de papas ya que influye en la cantidad de almidón que es degradado a glucosa, pues se favorece a temperaturas menores a 8°C, pero por estabilidad se almacenan a menores temperaturas (Friedman, 2003).
b) Condiciones de procesamiento durante el horneado y tostado de pan.
Surdyk et al. (2004) evaluaron el contenido de acrilamida en pan, encontrando que más del
99% de la acrilamida, se encuentra en la corteza, debido a las temperaturas alcanzadas, y además ese contenido está fuertemente relacionado con el color final adquirido. En otro estudio, se concluyó que un mayor tiempo de horneado causa un incremento en la concentración de acrilamida, y que las partes más tostadas o ennegrecidas del pan son las del contenido más alto de acrilamida, por lo que se recomienda como consumidor no tostar en exceso el pan, o raspar para remover las partes ennegrecidas (Friedman y Levin, 2008).
Otra opción es la fermentación de la masa, pues por ejemplo en masa de trigo y centeno para la elaboración de donas, permite una reducción en el contenido de asparagina, siendo ésta reducción directamente proporcional al tiempo de fermentación (Friedman y Levin, 2008).
c) Efecto de los ingredientes.
La adición o sustitución de algunos ingredientes puede ser benéfica o inducir un mayor desarrollo de acrilamida, como en el caso del bicarbonato de amonio que causa mayor desarrollo, en comparación con el uso de bicarbonato de sodio (Amrein et al., 2006). En cambio, la adición de glicina permite una reducción en el contenido de acrilamida, por lo que se sugiere rociarla sobre la superficie de la masa fermentada (Friedman y Levin, 2008).
El reemplazo de azúcares reductores por otros edulcorantes como la sacarosa (siempre y cuando no se realice también un descenso en el pH), y trehalosa permiten reducir el contenido de acrilamida, lo cual también ocurre con adición de ácido cítrico a sistemas con glucosa. Por otro lado, la adición de antioxidantes en alas de pollo fritas, papas fritas y galletas permite disminuir la cantidad final de acrilamida, a diferencia de lo ocurrido en té donde a pesar de los antioxidantes, la cantidad de acrilamida llega a ser muy alta.
Por tanto, aún son necesarios más estudios que permitan conocer sus efectos en la salud humana. Conclusiones
La acrilamida está presente en alimentos sometidos a altas temperaturas durante su procesamiento que involucran la reacción de Maillard principalmente entre la asparagina y la glucosa. Existen diversos métodos para la detección de acrilamida, sin embargo, debido a la gran diversidad de matrices alimenticias, no existe un método general aplicable a todas, por lo que es aún un tema a desarrollar y para investigar al respecto.
La información de diferentes estudios realizados demuestra manifestaciones de que la acrilamida y su principal metabolito, la glicidamida producen neurotoxicidad en seres humanos. Otros efectos como la carcinogénesis, problemas reproductivos, y genotoxicidad sólo se han comprobado en estudios con animales, no así en seres humanos. Sin embargo, los efectos adversos que se han comprobado sugieren que como consumidores, debemos tratar de consumir en menor cantidad aquellos alimentos en los que se ha encontrado alto contenido de acrilamida, y a nivel industrial, deben empezar a implementarse métodos que permitan su reducción, sin afectar las características de calidad del producto.
Referencias
Allan, S. 2002. Acrylamide angst: Another annoying distraction about food safety. Agrochemical and Environmental News. 198:2-13.
Amrein, T. M., Andres, L., Manzardo, G. y Amado, R. 2006. Investigations on the promoting effect of ammonium hydrogen carbonate on the formation of acrylamide in model systems. Journal of Agricultural and Food Chemistry. 54:10253-10261.
Anese, M., Suman, M. y Nicolo, M. C. 2009. Technological strategies to reduce acrylamide levels in heated foods. Food Engineering Reviews. 1:169179.
Becalsky, A., Lau, B. P., Lewis, D., y Seaman, S. 2003. Acrylamide in foods: occurrence, sources and modeling. Journal of Agricultural and Food Chemistry. 51:802-808.
Dunovská, L., Hajlová, J., Áajka, T, Holadová, K., Hájková, K. 2004. Changes in acrylamide levels in food products during technological processing. Czech Journal of Food Sciences. 22:283-286. Citado en: Masson, L., Muñoz, J.R., Romero, N., Camilo, C., Encina, C., Hernández, L., Castro, J. y Robert, P. 2007. Acrilamida en patatas fritas: revisión actualizada. Grasas y Aceites. 58(2):185193.
Ehling, S., Hengel., M., Shibamoto, T. 2005. Formation of acrylamide from lipids. En: M. Friedman y D.S. Mottram (Eds). Chemistry and safety of acrylamide in food. Springer, New York. pp. 223-234. Citado en: Friedman, M., y Levin, C. 2008. Review of methods for the reduction of dietary content and toxicity of acrylamide. Journal of Agricultural and Food Chemistry. 56:6113-6140.
El-Ziney, M. G., Al-Turki, A. A. y Tawfik, M. S. 2009. Acrylamide status in selected traditional Saudi foods and infant milk and foods with estimation of daily exposure. American Journal of Food Technology. 4(5):177-191.
Agradecimientos
A la Universidad de las Américas Puebla y al Consejo Nacional de Ciencia y Tecnología (CONACyT, México) por el financiamiento recibido para la realización de este trabajo.
Fan, X. y Mastovska, K. 2006. Effectiveness of ionizing radiation in reducing furan and acrylamide levels in foods. Journal of Agricultural and Food Chemistry. 54:8266-8270.
Friedman, M. 2003. Chemistry, biochemistry, and safety of acrylamide. A review. Journal of Agricultural and Food Chemistry. 51:4504-4526.
Friedman, M., y Levin, C. 2008. Review of methods for the reduction of dietary content and toxicity of
acrylamide. Journal of Agricultural and Food Chemistry. 56:6113-6140.
Gertz, C., Klostermann, S., Kochhar, P. 2003. Deep frying: the role of water from food being fried and acrylamide formation. Oléagineux, Corps Gras, Lipides. 10(4):297-303. Citado en: Masson, L., Muñoz, J. R., Romero, N., Camilo, C., Encina, C., Hernández, L., Castro, J. y Robert, P. 2007. Acrilamida en patatas fritas: revisión actualizada. Grasas y Aceites. 58(2):185-193.
Granda, C., Moreira, R. G. y Tichy, S. E. 2004. Reduction of acrylamide formation in potato crisps by low-temperature vacuum frying. Journal of Food Science. 69(8):405-411.
Hogervorst, J.G., Schouten, L.J., Konings, E.J., Goldbohm, A. y Van der Brandt, P. 2007. A prospective study on dietary acrylamide intake and the risk of endometrial, ovarian and breast cancer. Cancer Epidemiology, Biomarkers & Prevention. 16(11):2304-2313.
IARC. 1994. Acrylamide, IARC monographs on the evaluation of the carcinogenic risk of the chemicals to Humans. International Agency of Research on Cancer. 60. Citado en: El-Ziney, M. G., Al-Turki, A. A. y Tawfik, M. S. 2009. Acrylamide status in selected traditional Saudi foods and infant milk and foods with estimation of daily exposure. American Journal of Food Technology. 4(5):177-191.
Masson, L., Muñoz, J. R., Romero, N., Camilo, C., Encina, C., Hernández, L., Castro, J. y Robert, P. 2007. Acrilamida en patatas fritas: revisión actualizada. Grasas y Aceites. 58(2):185-193.
Mottram, D. S., Wedzicha, B. L. y Dodson, A. T. 2002. Acrylamide is formed in the Maillard reaction. Nature. 419:448-449. Citado en: Masson, L., Muñoz, J. R., Romero, N., Camilo, C., Encina, C., Hernández, L., Castro, J. y Robert, P. 2007. Acrilamida en patatas fritas: revisión actualizada. Grasas y Aceites. 58(2):185-193.
Mucci, L. A., Dickman, P. W., Steinek, G., Adami, H. O. y Augustsson, K. 2003. Dietary acrylamide and cancer of the large bowel, kidney and bladder. Absence of an association in a population based study in Sweden. Journal of Cancer. 88:84-89. Citado en: Friedman, M. 2003. Chemistry, biochemistry, and safety of acrylamide. A review. Journal of Agricultural and Food Chemistry. 51:4504-4526.
Pelucchi, C., Galeone, C., Levi, F., Negri, E., Franceschi, S., Talamini, R., Bosetti, C., Giacosa, A.
y La Vecchia, C. 2005. Dietary acrylamide and human cancer. International Journal of Cancer 118:467-471.
Rice, J. M. 2005. The carcinogenicity of acrylamide. Mutation Research. 580:3-20. Citado en Masson, L., Muñoz, J. R., Romero, N., Camilo, C., Encina, C., Hernández, L., Castro, J. y Robert, P. 2007. Acrilamida en patatas fritas: revisión actualizada. Grasas y Aceites. 58(2):185-193.
Romani, S., Bacchioca, M., Rocculi, P. y Rosa, M. 2008. Effect of frying time on acrylamide content and quality aspects of French fries. European Food Research and Technology. 226:555–560.
Sharma, A., Sharma, R. y Jain, J. 2008. Biochemical changes in the liver of Swiss albino mice orally exposed to acrylamide. Maejo International Journal of Science & Technology. 2(3):542-550.
Sorgel, F., Weissenbacher, R., Kinzig-Schippers, M., Hofmann, A., Illauer, M., Skott, A. y Landersdorfer, C. 2002. Acrylamide increased concentrations in homemade food and first evidence of its variable absorption from food, variable metabolism and placental and breast milk transfer In humans. Chemotherapy. 48:267-274. Citado en: Friedman, M. 2003. Chemistry, biochemistry, and safety of acrylamide. A review. Journal of Agricultural and Food Chemistry. 51:4504-4526.
Stadler, R. H., Blank, I., Varga, N., Robert, F., Hau, J., Guy, P. A., Robert, M. C. y Riediker, S. 2002. Acrylamide from Maillard reaction products. Nature. 419:449-450.
Surdyk, N. Rosén, J., Andersson, R. y Áman, P. 2004. Effects of asparagine, fructose and baking conditions on acrylamide content in yeast-leavened wheat bread. Journal of Agricultural and Food Chemistry. 52:2047-2051.
Taeymans, D., Wood, J., Ashby, P., Blank, I., Studer, A., Stadler, R., Gonde, P., Van Eijck, P., Lalljie, S., Lingnert, H., Lindblom, M., Matissek, R., Muller, D., Tallmadge, D., O´Brien, J., Thompson, S., Silvani, D. y Withmore, T. 2004. A Review of acrylamide: an industry perspective on research, analysis, formation and control. Critical Reviews in Food Science and Nutrition. 44:323-347.
Tareke, E., Rydberg, P., Karlsson, P., Eriksson, S. y Tornqvist, M. 2002. Analysis of acrylamide, a carcinogen formed in heated foodstuffs. Journal of Agricultural and Food Chemistry. 50:4998-5006.
Tyl, R., y Crump, K. 2002. Acrylamide in food. Fd. Std. Agency. 5:215-222. Citado en: Sharma, A., Sharma,
R. y Jain, J. 2008. Biochemical changes in the liver of Swiss albino mice orally exposed to acrylamide. Maejo International Journal of Science and Technology. 2(3):542-550.
WHO. 2002. Health implications of acrylamide in food. Report of a Joint FAO/WHO Consultation. Geneva, Suiza. Última consulta el 4 de noviembre de 2010. Disponible en: http://www.who.int/foodsafety/publications/chem/en /acrylamide_full.pdf
Wu, Y. Q., Yu, A. R., Tang, X. Y., Zhang, J y Cui, T. 1993. Determination of acrylamide metabolite,
mercapturic acid by HPLC. Biomedical and Environmental Sciences. 6:273-280. Citado en: Friedman, M. 2003. Chemistry, biochemistry, and safety of acrylamide. A review. Journal of Agricultural and Food Chemistry. 51:4504-4526.
Zyzak, D. V., Sanders, R. A., Stoianovic, M., Tallmadge, D. H., Eberhart, B. L., Ewald, D. K., Gruber, D. C., Morsch, T. R., Strothers, M. A., Rizzi, G. P. y Villagran, M. D. 2003. Acrylamide formation mechanism in heated foods. A review. Journal of Agricultural and Food Chemistry. 51:4504-4526.

Temas Selectos de Ingeniería de Alimentos 5 – 1 (2011): 11 – 21
Nanotecnología en alimentos
G. Soto - Chilaca* y A. López-Malo

Departamento de Ingeniería Química, Alimentos y Ambiental, Fundación Universidad de las Américas Puebla. Exhacienda Sta. Catarina Mártir S/N, Cholula, Puebla. C.P.72810. México.
Resumen
La nanotecnología ha sido definida como el arte de manipular la materia, átomo por átomo. Los materiales llamados “nano” tienen un tamaño entre 1 y 100 nanómetros. La nanotecnología en el área de los alimentos, tiene su aplicación en la calidad y la inocuidad alimentaria, el desarrollo de nuevos productos y el envasado, entre otros campos. La formación de nanopartículas, nanoemulsiones y nanocápsulas, permitirá mejorar el valor nutricional de los productos. En esta revisión se presenta el estado actual de la investigación y el desarrollo en la nanotecnología y su aplicación en la producción de alimentos. Después de una breve explicación de qué es la nanotecnología, se discuten las aplicaciones presentes y futuras esperadas en la agricultura y los alimentos.
Palabras clave: nanotecnología, alimentos, nanomateriales, nanopartículas.
Abstract
Nanotechnology has been defined as the art of manipulating matter, atom by atom. Nano materials have a size between 1 and 100 nanometers. Nanotechnology in food environment has its application in áreas as food quality and safety, development of new products, and packaging. The formation of nanoparticles, nanoemulsions and nanocapsules, will allow to improve the nutritional value of products. The aim of this review discusses the state of the arts and development in nanotechnology and its application in food production. After a brief explanation of what nanotechnology is, the present and expected future applications of nanotechnology in agricultura and food are discussed.
Keywords: nanotechnology, food, nanomaterials, nanoparticles.ár=
8 y después automático)
Introducción
La Nanotecnología es entendida como la capacidad de observar, manipular y controlar las propiedades de la materia a escala nanométrica (1 a 100 nm). El
*Programa de Doctorado en Ciencia de Alimentos
Tel.: +52 222 229 2126, fax: +52 222 229 2727
Dirección electrónica: gerardo.sotocha@udlap.mx
interés de la nanotecnología radica en el hecho de que ese pequeño tamaño conlleva propiedades físicas y químicas que difieren significativamente de las habituales a mayor escala. Con ello, muchos productos son más durables, resistentes, livianos, limpios o multifuncionales.
La mayor parte de las aplicaciones comerciales se centran en ingeniería de materiales, informática y medicina. Sin embargo, las aplicaciones en alimentos y agricultura crecen aceleradamente, debido a que se pueden mejorar la calidad y la seguridad de los mismos (Takhistoy et al., 2006). Hoy por hoy se puede ampliar su frontera de conocimiento gracias al desarrollo de instrumental novedoso, esto es, microscopios de fuerza atómica, microscopios de barrido, entre otros.
La Nanotecnología empieza a encontrar aplicaciones en el campo de los alimentos funcionales, modificando moléculas biológicas por medio de ingeniería, para proporcionarles funciones muy diferentes de las que tienen por naturaleza. Esto ha abierto todo un nuevo campo de investigación y desarrollo. Los alimentos son llamados nanoalimentos cuando se utilizan técnicas o herramientas nanotecnológicas o nanopartículas, durante su cultivo, producción, procesado o envasado (Paul et al., 2003).
La mayor parte de la investigación sobre nanotecnología en alimentos se ha centrado en el área de envasado como una nueva alternativa para crear envases de mayor calidad y mejor uso por parte de los consumidores. Los envases interactúan con los productos que contienen, preservando mejor la calidad. Se están desarrollando dos nuevas áreas de implantación comercial: nanotecnología en envases que detectan contaminantes peligrosos y nano-aditivos que son incorporado al envase con la finalidad de ser disueltos después en el producto final para preservar la calidad (Torres-Martínez et al., 2009).
Las últimas investigaciones se están centrando en las posibles aplicaciones en alimentos funcionales, nutracéuticos, y la detección de patógenos empleando para ello nanosensores. (Chen et al., 2006). Los
nanomateriales permiten una mejor encapsulación y liberación de los ingredientes activos en comparación con los agentes de encapsulación tradicionales. El desarrollo de nanoemulsiones, liposomas, micelas, biopolímeros complejos y cubosomas ha conducido al desarrollo de propiedades para la protección de compuestos bioactivos, sistemas de administración controlados, integración de matrices alimentarias y enmascaramiento de sabores no deseados (Takhistoy et al., 2006).
De aquí que el objetivo de esta revisión sea describir las aplicaciones de la nanotecnología en el área de alimentos, así como resaltar su importancia y las técnicas nanotecnológicas como nuevas herramientas para la manipulación de los alimentos.
Revisión bibliográfica
1. Nanotecnología
La nanotecnología tiene su origen en 1982 cuando se desarrolla el "microscopio de efecto túnel", el cual permite visualizar átomos como entidades independientes. Este desarrollo tecnológico permitió una base real para la evolución posterior de la manipulación de materia a escala muy pequeña (entre 10-7 m y 10-9 m). El premio Nóbel de Física de 1959, Feynman, a quien se considera el padre de la nanotecnología, mencionaba: "a medida que el ser humano tiene control de la disposición de moléculas y átomos, se pueden crear nuevos materiales con propiedades inimaginables" (Weiss et al., 2006).
Sin embargo, el término “nanotecnología” fue acuñado en 1974 por el profesor N. Taniguachi de la Universidad de Tokio, quien publicó un artículo titulado “Concepto básico de nanotecnología”. En este documento se habla por primera vez de la nanotecnología como la tecnología que permitiría separar,
consolidar y deformar materiales átomo a átomo o molécula a molécula.
El desarrollo de la nanotecnología a partir de la segunda mitad del siglo XX hasta nuestros días es evidente. La posibilidad de manipular la materia a una escala tan puntual como la atómica, sumada al descubrimiento de nuevas propiedades y funciones a ese nivel, genera un espectro inmenso de alternativas en la creación de dispositivos, materiales o sistemas, a todos los niveles industriales posibles. Muchas son las áreas de la ciencia que han estado, están y estarán involucradas en la nanotecnología; entre las actuales se encuentran: medicina, biología, farmacología y materiales, y en este campo, todas las aplicaciones en las áreas de ingeniería, como civil, construcción, electrónica, mecánica, química y alimentos, entre otras (Britton, 2008).
Los físicos, químicos, biólogos, ingenieros, científicos de materiales y otros científicos se unen en equipos interdisciplinarios para estudiar cómo se comporta la naturaleza a escala de átomos, y para tratar de integrar partículas de decenas de nanómetros de diámetro en potenciales productos. Otra utilización de esta tecnología es en la miniatura de chips micro-electrónicos, diseñados a escalas tan pequeñas que debe ser la mecánica cuántica la que determine su comportamiento electrónico para permitir, por ejemplo, la transmutación de un solo electrón (Nath y Chilkoti, 2007).
Los materiales y dispositivos con nanoestructuras tienen propiedades diferentes a los mismos materiales y dispositivos con mayor escala. Algunas de estas propiedades hacen posibles nuevos productos; por ejemplo el plástico nanoestructurado conduce electrones en lugar de ser un aislante (Roco, 2004). Se espera que esto permita microchips más baratos.
Existe un gran consenso en que la nanotecnología llevará a la humanidad hacia una segunda revolución industrial en el presente siglo. Supondrá numerosos avances para muchas industrias y nuevos materiales con propiedades extraodinarias (por ejemplo desarrollar materiales más fuertes que el acero), nuevas aplicaciones informáticas con componentes increíblemente más rápidos, o sensores moleculares capaces de detectar y destruir células cancerígenas en las partes más delicadas del cuerpo humano como el cerebro, entre otras muchas aplicaciones. Es posible afirmar que muchos progresos de la nanociencia estarán entre los grandes avances tecnológicos que cambiarán el mundo (Song et al., 2009).
Nanotecnología en México
En el caso de México se están haciendo esfuerzos para crear un programa nacional de nanotecnología, además de que existen grupos de trabajo y algunas redes de investigación en las principales universidades públicas y privadas que trabajan en nanomateriales, nanotubos, nanopartículas, nanocatalizadores e ingeniería molecular.
De acuerdo al reporte de nanotecnología de la Secretaría de Economía, en el periodo 19982004 se invirtió un total aproximado de $14.4 millones de dólares, el cual se distribuyó entre 152 proyectos de investigación administrados por 58 institutos. El 53% del presupuesto se asignó a investigación de nano materiales, 14% a química, 14% a electrónica, 12% a física y 7 % a otros. Por otro lado, en el 2008 México reportó 449 investigadores, 157 laboratorios, 17 plantas piloto y 340 líneas de investigación dedicados a la nanotecnología (SE, 2008).
No obstante, en comparación con lo que invirtieron los países que están a la vanguardia, es una cantidad muy pequeña. En la Tabla I se muestra el gasto estimado en

nanotecnología sólo en 2008 por parte de algunos países.
Esto da una idea de los países que son los grandes inversionistas en nanotecnología y los que determinan las tendencias competitivas en el mercado mundial. Es de resaltar que a diferencia de México, varios de estos países líderes en nanotecnología cuentan con iniciativas nacionales en la materia, lo que les permite identificar sectores de oportunidad y espacios de mercado a explotar (Ulloa, 2002).
También se puede observar la diferencia de México con respecto a otras economías emergentes, que han incluido a la investigación y el desarrollo de la nanotecnología en una iniciativa nacional y que, de manera paralela, han incrementado el financiamiento en este rubro. En la Tabla II se muestra la cantidad de artículos publicados entre los años 2000 y 2007, relacionados con la nanotecnología, lo cual sirve como un indicador de producción académico-científica al respecto (Záyago y Foladori, 2010).
2. Nanotecnología en alimentos
La nanotecnología alimentaria se encuentra aún en fase de crecimiento, tiene aplicaciones en la calidad, la seguridad alimentaria, el desarrollo de nuevos productos y el envasado, entre otras, aportando propiedades funcionales mejoradas, por ejemplo, un alimento con bajo contenido de sodio de sabor salado (Takhistoy et al., 2006).
La nanotecnología también puede mejorar los procesos de alimentos que utilizan enzimas para producir beneficios para la salud y nutricionales. La investigación y el desarrollo de la ciencia a escala nano ha tenido grandes descubrimientos, desde envases para alimentos con menor riesgo de migración de toxinas al alimento hasta técnicas para la detección de patógenos.
La aplicación de la nanotecnología en el campo de la alimentación permite la elaboración de alimentos más saludables, más resistentes y de mayor durabilidad. La

nanotecnología está adquiriendo cada vez más importancia y debido a sus numerosas y diversas aplicaciones en este campo seguirá innovando productos.
2.1 Aplicaciones de la nanotecnología en alimentos
Las aplicaciones de los materiales nanoestructurados y de las nanotecnologías para producirlos se están desarrollando con extrema rapidez, si bien desde hace mucho tiempo existen técnicas que permiten actuar a nivel nanoestructural, como son algunas áreas de la materia condensada, ciencia de coloides, crecimiento de películas, entre otros. El gran desarrollo en los campos de la biología molecular y la biotecnología a partir de los años 80, ha favorecido su expansión hacia todo tipo de materiales: metálicos, no metálicos, plásticos y compuestos, y a través de ello hacia los más diversos campos científicos, tecnológicos e industriales (Nguyen et al., 2007).
Se dan a continuación algunos ejemplos de las innumerables aplicaciones de esta tecnología, ya presentes en los mercados o cercanas a su comercialización:
Sensores destinados a detectar la presencia de compuestos específicos en diferentes
ambientes cerrados o abiertos, o aromas que caracterizan la calidad de bebidas y productos alimenticios.
Sistemas fotovoltaicos de alta eficiencia para conversión de la energía solar.
Nuevos materiales con una elevada relación resistencia/masa, para aplicaciones aeroespaciales, biomédicas y en medios de transporte.
Técnicas diagnósticas basadas en el sistema denominado “lab-on-a-chip”, para la realización de análisis clínicos y genéticos con mínimas cantidades de muestra y en tiempo real.
Cosméticos, en especial para la protección de la radiación solar.
Materiales para la filtración y catálisis de hidrocarburos y otras sustancias.
Revestimientos superficiales con resistencia a la corrosión, al rayado y al desgaste, notablemente mejorados.
Herramientas de corte de altísima tenacidad y fragilidad reducida.
Pantallas de video más livianas y funcionales, basada en la electrónica de polímeros.
Nuevas prótesis e implantes para colocación in vivo.
Técnicas de trabajo de piezas para micromecánica y microelectrónica en escala de 100 nm.
Algunas otras aplicaciones de la nanotecnología en las diferentes áreas se pueden observar en la Tabla III.
Estos materiales nanoestructurados se pueden obtener de dos maneras: una denominada “top down”, en la cual las nanoestructuras se esculpen sobre un bloque de material, y otra llamada “bottom up”, en la que los materiales nanoestructurados se obtienen a partir de nanopartículas. Las técnicas “top down” tienen similitud con las actuales técnicas de producción de microprocesadores electrónicos. Por su parte, las técnicas “bottom up” se basan en procesos similares a los utilizados en tecnología de materiales y pueden dar lugar a polvos, objetos compactos o capas delgadas, con propiedades profundamente cambiadas respecto a los mismos materiales obtenidos por tecnologías convencionales (Dutta y Hofmann, 2004).
Una de las primeras aplicaciones comerciales de la nanotecnología en el sector alimenticio fue en el envasado. Se estima que actualmente se están usando en el comercio entre 400 y 500 nano productos, y se prevé que en el año 2017 se utilizará nanotecnología en la manufactura del 25 % de todo el material
de envase de alimentos (Scrinis y Lyons, 2007).
Uno de los fines principales del nano envasado es lograr un mayor tiempo de conservación a través de la mejora de las funciones de barrera del material utilizado, a fin de reducir el intercambio de gases, la humedad y la exposición a los rayos ultravioleta. Por ejemplo, DuPont anunció que lanzaría al mercado un aditivo para plásticos compuesto por nanopartículas de dióxido de titanio, que reduciría el daño causado por los rayos ultravioleta a los alimentos en envases transparentes (Chaudhry et al., 2008).
También se están desarrollando nanomateriales de envasado que utilizan nanotubos de carbono y que tienen la capacidad de extraer oxígeno o dióxido de carbono (Roberts, 2007). En muchos casos, los envases pueden liberar agentes antioxidantes, sabores, fragancias o nutracéuticos en los alimentos y bebidas, a fin de prolongar su vida útil o mejorar su sabor y/o aroma o su valor nutricional (Chen et al., 2006).
Existen otros materiales de envasado y materiales en contacto con alimentos que, a

diferencia de los materiales de envasado que liberan sustancias químicas en función de determinadas circunstancias desencadenantes, tienen nanomateriales antimicrobianos incorporados de manera que el envase mismo actúa como agente antimicrobiano. Estos productos generalmente utilizan nanopartículas de plata, aunque algunos usan nanopartículas de óxido de zinc o dióxido de cloro. También se prevé que en el futuro se utilizarán nanopartículas de óxido de magnesio, óxido de cobre y nanotubos de carbono como materiales antimicrobianos para el envasado de alimentos (Bowman y Hodge, 2006).
Actualmente existen en el mercado diversos ingredientes activos nonoencapsulados que se utilizan para el procesamiento y conservación de bebidas, carnes, quesos y otros alimentos. A muchos alimentos se les agregan nanopartículas con el fin de mejorar las propiedades de flujo (por ejemplo, la facilidad de vertimiento), el color y la estabilidad durante el procesamiento, o de aumentar el tiempo de conservación de los productos.
Otra fuente creciente de nanopartículas en los alimentos son los aditivos nutricionales. La nanoencapsulación supone colocar ingredientes activos como vitaminas, hierro, magnesio, zinc y otros minerales, probióticos, péptidos bioactivos, antioxidantes, esteroles vegetales y enzimas, como fortificantes en productos lácteos, cereales, panes y bebidas (Chen et al., 2006).
La seguridad alimentaria es otra preocupación importante para los productores de alimentos. En la actualidad se están desarrollando nanosensores en el área de análisis químicos para ayudar a la seguridad alimentaria, permitiendo realizar pruebas rápidas de análisis en el producto terminado y mejorando el tiempo de respuesta, no sólo en la industria, sino también en los estantes (Alocilja y Radke, 2003).
Empresas como Kraft en conjunto con los investigadores de la Universidad Rutgers en Estados Unidos, están desarrollando una tira electrónica que se pueda incluir en los envases de los alimentos. Esta tira contiene nanosensores que son extremadamente sensibles a la liberación de gases del alimento. Haciendo que la tira cambie de color al contacto con los gases, el consumidor puede saber si el alimento está fresco o no (Wu et al., 2009). También se han creado nanosensores comestibles similares a un holograma que cambia de color indicando las presencia de microorganismos y la contaminación de frutas y vegetales (Britton, 2008).
Otra aplicación de nanotecnología en alimentos incluye nanopartículas que contienen antioxidantes encapsulados, lo cual ayuda a protegerlos de la destrucción en el tracto gastrointestinal, haciendo que lleguen en concentraciones hasta 70 % superiores al torrente sanguíneo, aumentando su capacidad benéfica para la salud. (Bowman y Hodge, 2007). En la Tabla IV se presentan más aplicaciones actuales de la nanotecnología en los alimentos.
Entre los métodos nanotecnológicos que se están empleando en el área de alimentos se encuentran:
a) Nanomicelas. Son partículas esféricas de 5 a 100 nanométros de diámetro. Se forman espontáneamente por la disolución de surfactantes en agua a concentraciones que exceden un nivel crítico, conocido como “concentración crítica de la micela”. Permiten encapsular moléculas no polares como lípidos, saborizantes, antimicrobianos, antioxidantes y vitaminas (Weiss et al., 2006).
Entre algunas aplicaciones exitosas de microemulsiones se incluyen la encapsulación de limoneno, licopeno, luteína y ácidos grasos omega 3. También la encapsulación de alfatocoferol para reducir la oxidación de los

lípidos en el aceite de pescado. Aquanova patentó en Europa una solución de isoflavonas, que consiste en isoflavonas de la soya encapsuladas dentro de micelas de alrededor de 30 nm de díametro; las micelas mejoran la absorción y biodisponibilidad de estas isoflavonas (Takhistoy et al., 2006).
b) Liposomas. Son formados por lípidos polares abundantes en la naturaleza, principalmente fosfolípidos. Éstos son esféricos con una configuración de concha de dos capas, pueden ser uni o multilamelares, conteniendo una o más conchas. Su tamaño varía entre 20 nm y unos cientos de micrómetros; su interior es acuoso por naturaleza. A diferencia de las nanomicelas, son usados para encapsular compuestos solubles en agua y en grasa (Paul et al., 2003).
El interior del liposoma tiene propiedades que se asemejan a las de un disolvente orgánico; proveen un micro-ambiente que permite mantener funcionalidad proteica. Algunos ejemplos son: liposomas que encapsulan lactoferrina para incrementar la vida media de los productos lácteos; fosvitina atrapada en liposomas para inhibir la oxidación de lípidos en una variedad de productos lácteos y carne molida de cerdo; la vitamina C encapsulada en liposomas para retener su actividad después de 50 días de almacenamiento refrigerado (por métodos tradicionales su actividad se pierde después de los 19 días) (Sanguansri y Augustin, 2006).
c) Nanoemulsiones. Son dispersiones muy finas de dos líquidos inmiscibles (generalmente de aceite en agua) con uno de
los líquidos siendo dispersado en el otro en forma de gotas; el diámetro de las gotas varía entre 50 y 200 nm. Se utilizan normalmente en el desarrollo de productos bajos en grasa. Un ejemplo son las mayonesas que incluyen nanopartículas de aluminio y silicona (Roco, 2004).
d) Nanopartículas biopoliméricas. Estas nanopartículas consisten de una matriz de biopolímeros que están conectados a través de fuerzas intermoleculares de atracción o de enlaces covalentes para formar partículas sólidas. Las nanopartículas pueden consistir de un biopolímero simple o tener una estructura de concha interior (Sanguansri y Augustin, 2006).
Existe una amplia variedad de biopolímeros naturales y sintéticos que han sido usados para encapsular y transportar compuestos, entre los que se encuentran: el quitosano un polímero antimicrobiano y antioxidante obtenido de las conchas de crustáceos, y el poli-láctico que se utiliza por su capacidad para inhibir el crecimiento bacteriano y de hongos (Des Rieux et al., 2006).
2.2 Aplicaciones de la nanotecnología en agricultura
La nanotecnología está introduciendo toda una nueva gama de plaguicidas, reguladores de crecimiento vegetal y fertilizantes químicos. Las compañías agroquímicas han reducido el tamaño de las partículas de las emulsiones químicas existentes, llevándolas a dimensiones nanoscópicas, o han encapsulado los ingredientes activos en nanocápsulas diseñadas para abrirse bajo ciertas condiciones, por ejemplo, en respuesta a la luz solar, el calor o las condiciones alcalinas en el estómago de un insecto (Luykx et al., 2008). De igual manera que con las nanocápsulas y nanoemulsiones que se están desarrollando en los sectores de alimentos y envasado, la finalidad de reducir el tamaño de las
nanopartículas y emulsiones usadas en agroquímicos es hacerlas más potentes (Fang et al., 2009).
Así se tiene a los pesticidas inteligentes o nanocidas de las empresas Syngenta, Monsanto y BASF que han sido aprobados en Inglaterra y Estados Unidos. Los nanocidas usan un sistema de liberación controlada, ya que se encuentran en pequeñas cápsulas de polímeros, que son modificadas para que se adhieran específicamente a las partes de la planta que necesitan ser protegidas de los insectos. Estas nanocápsulas se mantienen inertes hasta que el insecto empieza a consumir la planta, son los jugos digestivos específicos del insecto los que liberan el pesticida dentro del cuerpo, aniquilándolo (Scrinis y Lyons, 2007).
Otras compañías emplean dispersiones de nanopartículas (nonoemulsiones) que pueden tener base hídrica o de aceite, y que contienen suspensiones uniformes de nanopartículas pesticidas o herbicidas en el espectro de los 200 a 400 nm (Joseph y Morrison, 2006). En la Tabla V se presenta información sobre nanoagroquímicos que se están desarrollando.
Conclusiones
Las aplicaciones socioeconómicas, científicas, industriales, tecnológicas, agroalimentarias y sanitarias de la nanotecnología sólo están limitadas a mediano y largo plazo por la imaginación y capacidad creativa de los científicos. En varios países, los gobiernos y las empresas están invirtiendo en cientos de proyectos de desarrollo de nanotecnología en los alimentos y la agricultura.
La nanotecnología puede ser aplicada en todos los aspectos de la cadena alimentaria, tanto para mejorar la seguridad y el control de

calidad, como en nuevos ingredientes alimentarios o complementos.
No obstante, se requiere más investigación para comprender el modo en que las nanopartículas se pueden emplear en la industria de los alimentos. Se sabe poco acerca de la forma en que estas partículas son absorbidas y excretadas por el organismo y sobre todo de cómo se desplazan por el mismo. Agradecimientos
A la Universidad de las Américas Puebla y al Consejo Nacional de Ciencia y Tecnología (CONACyT, México) por el financiamiento recibido para la realización de este trabajo.
Britton, S. 2008. High cost of nanotechnology means manufacturers miss out. Food Manufacture 24:657659
Bowman, D. y Hodge, G. 2006. Nanotechnology: mapping the wild regulatory frontier. Futures 38:1060-1073.
Bowman, D. y Hodge, G. 2007. A small matter of regulation: An international review of nanotechnology regulation. Columbia Science Technology Law Rev. 8:1-32.
Chaudhry, Q., Scotter, M., Blackburn, J., Ross, B., Boxal, A. L., Castl, L. 2008. Applications and implications of nanotechnologies for the food sector. Food Additives & Contaminants: Part A. 25: 241258,
Chen, H., Weiis, J. y Shahidi, F. 2006. Nanotechnology in nutriceuticals and functional foods. Food Technology. 60:3-8.
Des Rieux, A., Fievez, V., Garinot, M., Schneider, Y.J. y Preat, V. 2006. Nanoparticles as potential oral delivery systems of proteins and vaccines: a mechanistic approach. Journal of Control Release. 116 (1):1-27.
Referencias
Alocilja, E.C. y Radke, S.M. 2003. Market analysis of biosensors for food safety. Biosensors and bielectronics. 18:841-846
Dutta, J. y Hofmann, H. 2004. Self-Organization of colloidal nanoparticles. Encyclopedia of Nanoscience and Nanotechnology, 9: 617-640.
Fang, G., J. He, C. Zhang, K. Qian and S. Wang. 2009. Carbon nanotubes as matrix solid-phase dispersion extraction absorbents to determine 31 pesticides in
samples by gas chromatography-mass spectrometry. Journal of Agricultural and Food Chemistry. 10: 1021-1029.
Joseph, T. y Morrison, M. 2006. Nanotechnology in agriculture and food. Nanoforum Report. http://www.nanoforum.org/dateien/temp/nanotechno logy%20in%20agriculture%20and%20food.pdf?081 22006200524, accesada 7/02/2011.
Luykx, D., Peters, J.B., Saskia M. y Bouwmeester, H. 2008. A review of analytical methods for the identification and characterization of nano delivery systems in food. Journal of Agricultural and Food Chemistry. 56: 8231-8247.
Nath, N., y Chilkoti, A. 2007. A colorimetric gold nanoparticle sensor to interrogate biomolecular interactions in real time on a surface. Analytical Chemistry. 74: 504-509
Nguyen, B.T., Gautrot, J.E., Nguyen, M.T. y Zhu, X.X. 2007. Nitrocellulose-stabilized silver nanoparticles as low conversion temperature precursors useful for inkjet printed electronics. Journal of Materials Chemistry. 17: 1725- 1730.
Paul, W., Hebert, F. y Sinkula G. 2003. Investing in nanotechnology. Nature Biotechnology. 21: 10-16.
Roberts, R. 2007. The role of nanotechnology in brand protection. Packaging Digest. Enero de 2007. http://www.packagingdigest.com/articles/200701/34 .php, accesada 8/02/2011.
Roco, M. 2004. Nanoscale science and engineering: unifying and transforming tools. Journal American Institute of Chemical Engineers. 50 (5): 1023 -1031.
Sanguansri, P., y Augustin, M. 2006. Nanoscale materials development: A food industry perspective. Trends Food Science Technology. 17: 547-556.
Sanguansri, P., Augustin, M.A., Weiss, J., Takhistov P., McClements D.J. 2006. Functional materials in food
nanotechnology. Journal of Food Science. 72: R107R116.
Scrinis, G. y Lyons, K. 2007. The emerging nanocoperate paradigm: nanotechnology and the transformation of nature, food and agrifood systems. International Journal of Sociology of Food and Agriculture. 15 (2): 22-44.
SE (Secretaria de Economía). 2008. Diagnostico y prospectiva de la nanotecnología en México. www.economia.gob.mx/pics/pages/944_base/Nanot ecnologia.pdf, accesada 10/02/2011.
Song, Y.Y., Schmidt-Stein, F., Bauer, S. y Schmuki P. 2009. Amphiphilic TiO2 nanotube arrays: An actively controllable drug delivery system. Journal of the American Chemical Society. 131: 4230-4232.
Takhistoy, P., Weiss, J. y McClements, J. 2006. Food nanotechnology. Journal of Food Science. 71: 9-14.
Torres-Martínez, T.C, Nguyen, L. R., Kho M. 2009. Biomolecularly capped uniformly sized nanocrystalline materials: glutathione-capped ZnS nanocrystals. Nanotechnology. 10: 340-354.
Ulloa, S.E. 2002. Nanoscience in Latin America. Journal of Nanoparticles Research. 4 (3): 175-177.
Weiss, J., Takhistoy, P. y McClements D.J. 2006. Functional materials in food nanotechnology. Journal of Food Science. 719: R107- R116.
Wu, Y., Na, N., Zhang S., Wang, X., Liu, D. y Zhang, X. 2009. Discrimination and identification of flavors with catalytic nanomaterial based optical chemosensor array. Analytical Chemistry. 81: 961966.
Záyago., L. y Foladori, G. 2010. La nanotecnología en México: un desarrollo incierto. Economía, Sociedad y Territorio. 32: 143-178.

Temas Selectos de Ingeniería de Alimentos 5 – 1 (2011): 22 - 31

Procesos avanzados de oxidación y su aplicación en alimentos
V. Aurioles-López*1, A. López-Malo Vigil1, E. R. Bandala2
1Departamento de Ingeniería Química, Alimentos y Ambiental. 2Departamento de Ingeniería Civil y Ambiental. Fundación Universidad de las Américas Puebla. Exhacienda Sta. Catarina Mártir S/N, Cholula, Puebla. C.P.72810. México.
Resumen
La presencia de microorganismos patógenos en los alimentos es un problema de inocuidad alimentaria, que se trata de evitar a partir de buenas prácticas de producción, así mismo se han buscado métodos efectivos en la desinfección de los alimentos. En la actualidad se están evaluando nuevas tecnologías que cumplan con las expectativas de sanidad necesarias para brindar productos de calidad. Los procesos avanzados de oxidación (PAOs) han probado ser efectivos en la remoción de compuestos orgánicos en agua, y últimamente se está evaluando su eficiencia en la inactivación de microorganismos. Por tal motivo, la presente revisión bibliográfica intenta dar a conocer la aplicación de los PAOs en la inactivación de microorganismos en frutas y hortalizas, como una alternativa segura y novedosa para su desinfección.
Palabras clave: procesos avanzados de oxidación, inactivación de microorganismos, alimentos.
Abstract
Presence of pathogens in food is a concerning safety problem. Attempts to remediate this problem includes good manufacturing practices and the sought of effective methods for disinfecting food. A mandatory task related is evaluating new technologies that meet health expectations necessary to provide quality products. Advanced oxidation processes (AOPs) are cost-effective technologies which have proved high efficiency in removing organic compounds in water as well as in the inactivation of microorganism. Therefore, the present review aims to explain the implementation of AOPs in the inactivation of microorganisms in fruits and vegetables, as a safe and novel disinfection procedure.
Keywords: advanced oxidation process, inactivation of microorganisms, food.
Introducción
Existe cierta problemática en cuanto a la inocuidad en los alimentos que son consumidos frescos y/o crudos, como es el caso de las frutas y hortalizas, las cuales están expuestas a diversos agentes contaminantes a lo largo de la cadena alimentaria hasta su consumo. En el caso de su contaminación, estos alimentos pueden provocar brotes de enfermedades que pueden llegar a ser de difícil control. En la actualidad se han desarrollado diversos métodos de conservación de los
*Programa de Doctorado en Ciencia de Alimentos
Tel: +52 222 229 2126, fax: +52 222 229 2727
Dirección electrónica: veronica.aurioleslz@udlap.mx
alimentos, los cuales presentan limitaciones en cuanto a su efectividad, accesibilidad o costo, y que, además, pueden afectar la calidad sensorial de los alimentos y generar subproductos no deseables para el ambiente. De aquí que la necesidad de buscar alternativas que contrarresten esas limitaciones es de gran importancia desde el punto de vista de la salud, del económico y de la calidad sensorial del alimento.
Actualmente se conocen procesos químicos que favorecen la mineralización de compuestos orgánicos de difícil degradación. Estas tecnologías, llamadas emergentes, proporcionan alta efectividad en la remoción de contaminantes y desinfección de agua, y reciben el nombre de procesos avanzados de oxidación (PAOs). Dichos procesos están ganando popularidad debido a su alta eficiencia y además son considerados amigables con el ambiente.
Los PAOs están siendo utilizados también como alternativa en la inactivación de microorganismos, principalmente patógenos, en un principio para la desinfección de agua; sin embargo, actualmente se está explorando la posibilidad de que sean útiles en la inactivación de microorganismos presentes en alimentos.
El objetivo de este artículo de revisión es dar a conocer la aplicación de los procesos avanzados de oxidación en la desinfección de frutas y hortalizas.
y Dionysiou, 2003; Bankian-Tabrizi y Mehrvar, 2004; Bandala et al., 2007, 2009; Silva et al., 2009). Han sido aplicados satisfactoriamente en la descontaminación de agua con una amplia variedad de productos químicos tales como plaguicidas, fenoles, hidrocarburos, agentes tensoactivos, colorantes, entre otros (Bandala et al., 2007), y recientemente se ha demostrado su aplicación en la inactivación de microorganismos (Domenech et al., 2004; Lonnen et al., 2005; Guisar et al., 2007; Bandala et al., 2009; Muranyi et al., 2010).
Los PAOs involucran la generación de especies oxidantes altamente reactivas capaces de atacar y degradar sustancias orgánicas (Glaze, 1987; Bolton, 2001). Las especies reactivas de oxígeno (EROs) son moléculas de alta reactividad debido a que en el último orbital tienen un electrón no pareado (radical libre), lo cual confiere inestabilidad física. Las principales EROs son: radical hidroxilo (•OH), peróxido de hidrógeno (H2O2), anión superóxido (O2-), oxígeno singulete (1O2), óxido nítrico (NO), peróxido (ROO), semiquinona (Q) y ozono (O3) (Mittler, 2002).
Revisión bibliográfica
1. Procesos avanzados de oxidación (PAOs)
Los procesos avanzados de oxidación (PAOs), son los procesos químicos de oxidación más eficaces en el tratamiento de agua (Anipsitakis
Existe un especial interés en los procesos que generan el radical hidroxilo (•OH), debido a que el •OH es un oxidante extremadamente activo y no selectivo, capaz de oxidar una amplia variedad de compuestos de difícil degradación (Zhou y Smith, 2002; Pera-Titus et al., 2004; Amat et al., 2005). Este radical puede ser generado por medios fotoquímicos (incluida la radiación solar) y otras formas de energía, y posee alta efectividad para la oxidación de materia orgánica (Bolton et al., 2001; Domenech et al., 2004).
La reacción de Fenton es uno de los PAOs más utilizado para el tratamiento de contaminantes en solución acuosa. Esta reacción se lleva a cabo mediante una mezcla de sales ferrosas (Fe2+) y peróxido de hidrógeno (H2O2), que da como resultado la
generación de radicales hidroxilo (•OH), de acuerdo con la ecuación (1):
Fe2+ + H2O2 Fe3+ + •OH + -OH (1)
Los PAOs tienen dos derivaciones principales (Domenech et al., 2004):
Los procesos no fotoquímicos que originan especies reactivas potentes, principalmente el radical hidroxilo, a través de la transformación de especies químicas o mediante la utilización de distintas formas de energía, con excepción de la irradiación luminosa.
Y los procesos fotoquímicos, que son aquellos métodos que utilizan de una manera u otra alguna fuente de radiación (BankianTabrizi y Mehrvar, 2004). La presencia de ésta aumenta la velocidad de reacción en comparación con la misma técnica en su ausencia, además de ampliar la flexibilidad del
sistema debido a que permite el uso de una variedad de oxidantes y condiciones de operación.
En la Tabla I se muestran los procesos no fotoquímicos y fotoquímicos mayormente utilizados y que involucran la generación del radical •OH. Estos procesos implican métodos muy diferentes de activación, así como la generación de oxidantes que pueden utilizar una serie de mecanismos diferentes para la eliminación de contaminantes orgánicos; sin embargo, comparten la química del radical hidroxilo para la remoción de contaminantes (Bolton et al., 2001).
Por otro lado, además de la eficiencia de los diversos PAOs en el tratamiento de agua, se ha demostrado su eficiencia en la inactivación de microorganismos mediante dos PAOs en particular, los procesos fotocatalíticos homogéneos y heterogéneos (Srinivasan y Somasundaram, 2003; Guisar et al., 2007; Bandala et al., 2009).
Tabla I. Procesos avanzados de oxidación que involucran principalmente el radical •OH
Procesos no fotoquímicos
Ozonización en medio alcalino (O3/OH-)
Ozonización con peróxido de hidrógeno (O3/H2O2)
Procesos Fenton (Fe2+/H2O2) y relacionados
Oxidación electroquímica
Radiólisis y tratamiento con haces de electrones
Plasma no térmico
Descarga electrohidráulica - Ultrasonido
Oxidación en agua sub/y supercrítica
Domenech et al. (2004).
Procesos fotoquímicos
Procesos fotoquímicos
Fotólisis del agua en el ultravioleta de vacío (UVV)
UV/peróxido de hidrógeno
UV/O3
Foto-Fenton y relacionadas
Fotocatálisis heterogénea
Los PAOs presentan algunas ventajas sobre otros métodos de descontaminación, principalmente, su capacidad para destruir compuestos orgánicos en el agua sin el traslado a otro medio o generar problemas secundarios en la eliminación de residuos (Bankian-Tabrizi y Mehrvar, 2004). Esto se debe a que cambian químicamente el contaminante y se puede lograr una destrucción completa del mismo; este proceso es llamado mineralización. Además, estos métodos se pueden usar solos o combinados entre ellos o con métodos convencionales, pudiendo ser aplicados también a contaminantes de aire y suelo. Permiten incluso la desinfección por inactivación de bacterias y virus (Domenech et al., 2004).
Otra ventaja es la baja concentración en la cual son funcionales, llegando a generar remoción de partes por billón (ppb). Mejoran además los atributos sensoriales del agua tratada y, en muchos casos, consumen menos energía que otros tratamientos alternativos. Al mismo tiempo, elimina efectos sobre la salud causados por desinfectantes y oxidantes como el cloro y el permanganato de potasio (Domenech et al., 2004).
1.1. Fotocatálisis homogénea
Este proceso se lleva a cabo ya sea por la radiación directa de la oxidación catalítica en el contaminante o mediada por el peróxido de hidrógeno (UV/H2O2), por ozono (UV/O3), o por ambos (UV/H2O2/O3) (Bolton et al., 2001).
La velocidad de generación de radicales •OH mediante la reacción Fenton se ve ampliamente favorecida con la aplicación de radiación ultravioleta (UV). Al proceso fotoasistido se le conoce como sistema fotoFenton (Rodríguez et al., 2010) y de forma general se representa por la ecuación (2):
Fe3+ +H2O + hv Fe2+ + •OH + H+ (2)
El efecto positivo de la irradiación sobre la producción de los •OH se debe a que esta energía favorece la regeneración fotoquímica de los iones ferrosos (Fe2+), a través de la fotoreducción de los iones férricos (Fe3+). Sin embargo, la reacción de catálisis homogénea puede necesitar hasta 50 u 80 mg/L de hierro en solución, y esta necesidad puede estar por encima de lo autorizado para la descarga directa en el ambiente por el tratamiento de agua (Herney-Ramírez et al., 2008).
1.2. Fotocatálisis heterogénea
Es un proceso que se basa en la absorción directa o indirecta de energía radiante (visible o UV) por un sólido que es el fotocatalizador heterogéneo, que normalmente es un semiconductor, por ejemplo, dióxido de titanio (TiO2), sulfuro de zinc (ZnS), silicio (Si), óxidos de hierro, entre otros (Bolton et al., 2001).
La reacción de destrucción o de remoción de los contaminantes ocurre en la región interfacial entre el sólido excitado y la solución, sin que el catalizador sufra cambios químicos. La excitación del semiconductor puede tener lugar de dos formas (Domenech et al., 2004):
a) Por excitación directa del semiconductor, de manera que éste es el que absorbe los fotones usados en el proceso.
b) Por excitación inicial de moléculas adsorbidas en la superficie del catalizador, las que a su vez son capaces de inyectar cargas (electrones) en el semiconductor.
La fotocatálisis heterogénea recurre además a reductores químicos que permiten realizar transformaciones en contaminantes tóxicos poco susceptibles a la oxidación, como iones metálicos o compuestos halogenados (Domenech et al., 2004).
La principal ventaja de este proceso es su compatibilidad con el ambiente, debido a que usa un reactivo limpio, el electrón (Rodríguez et al., 2010).
2. Inactivación de microorganismos patógenos
La presencia de microorganismos patógenos genera alto riesgo para la salud de los ecosistemas y de los humanos. Por tal motivo, es importante la identificación de los mismos; sin embargo, muchos de los indicadores que se han utilizado en estudios de investigación no son adecuados para el seguimiento y vigilancia de rutina, debido al costo y la dificultad de medición con equipo limitado (Campos, 2008).
Los organismos indicadores son utilizados
para evaluar el riesgo asociado al uso de agua residual en la agricultura en diferentes situaciones (Campos, 2008). Estos indicadores pueden estar directamente relacionados con enfermedades de las poblaciones humanas, por consumo de agua o alimentos. Algunos de los microorganismos indicadores y patógenos se muestran en la Tabla II.
Asimismo, es importante la eliminación de microorganismos peligrosos para la seguridad ambiental y humana.
En la utilización de los PAOs como método alternativo de desinfección, se ha sugerido que el principal mecanismo en la inactivación de microorganismos es el daño celular (Srinivasan y Somasundaram, 2003) que puede conducir a la liberación de ácidos
Tabla II. Ejemplos de indicadores patógenos para humanos.
Patógenos para los humanos
Microorganismo indicador
Bacteria: E. coli, coliformes fecales,
Shigella coliformes totales,
Escherichia coli (enterotoxigénica) enterococos
Campylobacter
Vibrio cholerae
Virus:
Adenovirus
Rotavirus
Enterovirus
Hepatitis A
Norovirus (“Norwalk-Like Viruses” NLV)
Protozoarios:
Cryptosporidium (ooquistes)
Giardia (quistes)
Helmintos:
Ascaris lumbricoides
Trichuris trichuris (huevos)
Modificada de Campos (2008).
Bacteriófagos
Colifagos somáticos
Fagos ARN-F
Clostridium perfringens
Ascaris (huevos)
nucleicos (Wang et al., 2007). El daño celular es producido por especies reactivas de oxígeno generadas por la reacción de compuestos tales como oxígeno (O2) o peróxido de hidrógeno (H2O2), así como por las interacciones particulares físicas y químicas entre los compuestos y los organismos (Kim et al., 2010).
Se sabe que las especies reactivas de oxígeno (EROs) se pueden generar en los organismos a partir de procesos endógenos como la respiración celular y la fagocitosis, pero también mediante procesos exógenos como la radiación UV. Además, los organismos cuentan con un sistema de defensa antioxidante encargado de controlar a las EROs (Gil del Valle et al., 1999). Por otro lado, las EROs son indispensables para ciertos procesos bioquímicos involucrados en el señalamiento celular (Mittler, 2002), y están asociadas con la respuesta inmune de los seres vivos (Swindle y Metcalfe, 2007). Sin embargo, la producción excesiva o inapropiada de EROs puede generar un desequilibrio en la producción de antioxidantes y desencadenar “estrés oxidativo”, el cual tiene efectos altamente tóxicos al oxidar moléculas básicas como proteínas, ácidos nucleicos, carbohidratos y lípidos, mientras que la acumulación de EROs puede ocasionar muerte celular (Mittler, 2002).
Se ha reportado la eficiencia de los PAOs en la inactivación de microorganismos, principalmente en Escherichia coli. Sin embargo, esta bacteria puede ser menos resistente a la desinfección que otras bacterias entéricas como Shigella y Salmonella (Rivera et al., 2010).
Por otro lado, se han realizados estudios sobre el uso de los PAOs para la inactivación de una amplia variedad de microorganismos, mostrando su efectividad. Entre algunos microorganismos estudiados están: parásitos
como Cryptosporidium parvum (Cho y Yoon, 2008), esporas de Bacillus subtilis (Lonnen et al., 2005; Cho y Yoon, 2008; Bandala et al., 2009), Pseudomonas aeruginosa y levaduras como Candida albicans (Lonnen et al., 2005), virus como el colifago MS2 (Kim et al., 2010) e incluso hongos del género Fusarium (Lonnen et al., 2005; Sichel et al., 2007); evidenciando así la potencialidad de los PAOs en la inactivación de microorganismos.
3. Aplicación de PAOs en la desinfección de alimentos
Los microorganismos patógenos en alimentos son la principal causa de enfermedades transmitidas por estos productos. Por tal motivo, es indispensable mantener un adecuado control de su calidad microbiana (Garret, 2002).
En el caso particular de las frutas y hortalizas, que son productos consumidos generalmente frescos, es evidente la asociación con brotes de enfermedades debidas principalmente a un inadecuado tratamiento de desinfección (Garret, 2002).
Estos alimentos habitualmente llevan un proceso de limpieza a través de diversos métodos desinfectantes como son la utilización de hipoclorito de sodio, ácidos orgánicos, radiación UV, peróxido de hidrógeno, ozono, entre otros. Sin embargo, muchos de ellos pueden afectar las características sensoriales de los alimentos (Parish et al., 2003), y generar subproductos de difícil degradación provocando deterioro ambiental; además de necesitar equipos especializados de alto costo (Kim et al., 2009).
Actualmente, se está en la búsqueda de tratamientos alternativos que desinfecten adecuadamente los alimentos, que no provoquen cambios sensoriales indeseables, que sean seguros para los consumidores, y que sean tecnologías limpias. Una opción que está
siendo evaluada es la utilización de los PAOs como alternativa de desinfección.
Estas tecnologías han sido aplicadas exitosamente en la desinfección de frutas y hortalizas, como lo mencionan Cho et al. (2007) quienes sometieron zanahorias al tratamiento heterogéneo UV/TiO2, mostrando una inactivación de Escherichia coli, Salmonella Typhimurium y Bacillus cereus, superior a la lograda en el tratamiento con radiación UV. Las zanahorias tratadas con los diferentes métodos de desinfección, fueron almacenadas durante 21 días a 4 ⁰C, para su posterior análisis sobre la población de bacterias aerobias totales, observando un incremento mayor en las zanahorias desinfectadas con UV en comparación con las tratadas con UV/TiO2. Los autores observaron 3.1 y 2.4 log UFC/ml después del tratamiento con UV y UV/TiO2 respectivamente, de una población inicial aproximada de 4.2 log UFC/ml, y un incremento a 6.0 y 4.4 y log UFC/ml respectivamente, a los 21 días de almacenamiento. Por otro lado, Cho et al. (2007) mencionan la necesidad de inmovilizar las partículas de TiO2 en la superficie de tubos de cuarzo, debido a que se ha reportado que este compuesto puede causar inflamación pulmonar crónica en animales y humanos. La inmovilización de TiO2 puede reducir los efectos adversos de su presencia en los alimentos. Sin embargo, es necesaria la regulación para determinar la seguridad del tratamiento con TiO2 por agencias especializadas (Cho et al., 2007).
Kim et al. (2009) probaron la efectividad de la reacción generada por el tratamiento de UV/TiO2 en la desinfección de Escherichia coli, Listeria monocytogenes, Staphylococcus aureus y Salmonella Typhimurium en lechuga “iceberg”, en comparación con otros métodos de desinfección utilizados comúnmente. La máxima reducción microbiana para el tratamiento con UV/TiO2 fue de 2.6, 2.5, 2.3 y
2.8 log UFC/ml respectivamente, en comparación con el tratamiento de UV que mostró reducción de 1.4, 1.0, 1.4 y 1.4 log UFC/ml respectivamente; y mayor también comparada con la reducción de la carga microbiana con NaClO que fue de 0.9, 0.8, 0.9 y 1.1 log UFC/ml (Kim et al., 2009). Los mismos autores evaluaron también el recuento de las bacterias aerobias totales después del almacenamiento durante 9 días a 4 °C, encontrando un incremento de 1.2, 1.6 y 1.3 log UFC/ml para los tratamientos UV/TiO2, UV y NaClO, respectivamente (Kim et al., 2009).
En un estudio realizado por Corwe et al. (2007) se demostró la inactivación de microorganismos como Enterobacter agglomerans y Pseudomonas fluorescens, presentes en el arándano azul (Vaccinium angustifolium), causantes del deterioro postcosecha en este fruto. Se encontró que el tratamiento de limpieza con O3/H2O2/UV es más efectivo en comparación al tratamiento con radiación UV, atribuyendo la diferencia a que la radiación UV sólo es efectiva en la superficie del arándano.
Por otro lado, Selma et al. (2008) determinaron la calidad microbiana del agua posterior al lavado de algunas hortalizas infectadas intencionalmente con microorganismos, demostrando la alta eficacia del tratamiento de UV/TiO2 en la inactivación microbiana. Se logró la inactivación total para Listeria spp. en el agua de lavado de escarola y achicoria, y alta inactivación de Listeria spp. y Escherichia coli en lechuga, atribuyendo la disminución de células viables a la acción del radical hidroxilo (•OH) sobre las mismas (Selma et al., 2008).
En la Tabla III se resume la efectividad de desinfección sobre microorganismos, a partir de fotocatálisis heterogénea sobre productos frescos, mostrándose el decremento de las
22 - 31
Tabla III. Eficacia de PAOs utilizados para la inactivación de algunos microorganismos en frutas, hortalizas así como el agua de lavado de algunas hortalizas.
Producto Microorganismo
Arándano azul Crowe et al (2007)
Zanahoria
Cho et al. (2007)
Enterobacter agglomerans
flourescens
coli
Lechuga iceberg
Kim et al. (2009)
Listeria monocytogenes
aureus
Typhimurium
Agua de lavado de
Lechuga Escherichia coli
Listeria spp.
Selma et al. (2008)
UFC: Unidades formadoras de colonias
unidades formadoras de colonias por mililitro (UFC/ml).
Es claro que la aplicación de tecnologías alternativas como los PAOs en la inactivación de microorganismos, proporcionan alta efectividad que otros tratamientos; sin embargo es necesaria mayor investigación para su utilización sobre frutas y hortalizas.
Conclusiones
A pesar de que los PAOs han demostrado su efectividad en la desinfección de agua, y pueden ser una alternativa en la inactivación de microorganismos patógenos, y además de que se ha probado mayor eficiencia de los PAOs en la desinfección de frutas y hortalizas en comparación con algunos métodos
convencionales, es necesaria mayor investigación en su utilización sobre alimentos como frutas y hortalizas. Siendo esta aplicación relativamente nueva, dicha investigación debe estar encaminada a la regulación de los posibles materiales a utilizar, para la seguridad de los consumidores, así como quizá hacia la combinación con métodos convencionales y evaluar el potencial desinfectante. Considerando los posibles cambios en los atributos sensoriales de las frutas y hortalizas desinfectadas con estos tratamientos así como la evaluación de la inocuidad durante su almacenamiento posterior.
fenton-like advanced oxidation processes Journal of Environmental Science and Health. Part-B 42:21-26
Bandala, E. R., Corona-Vásquez, B., Guisar, R. y Uscanga, M. 2009. Deactivation of highly resistant microorganisms in water using solar driven photocatalytic processes. International Journal of Chemical Reactor Engineering 7:A7.
Bolton, J. R. 2001. Ultraviolet applications handbook. Segunda edición. Bolton Photosciences Inc. Ontario, Canadá. 628 p.
Bolton, J., Bircher, K.G., Tumas, W. y Tolaman, Ch. A. 2001. Figures-of-merit for the technical development and application of advanced oxidation technologies for both electric- and solar-driven systems. Pure and Applied Chemistry. 73:627-637.
Agradecimientos
A la Universidad de las Américas Puebla y al Consejo Nacional de Ciencia y Tecnología (CONACyT, México) por el financiamiento recibido para la realización de este trabajo.
Campos, C. 2008. New perspectives on microbiological water control for wastewater reuse. Desalination. 218:34-42.
Crowe, K. M., Bushway, A. A., Bushway, R. J., DavisDentici, K. y Hazen, R. A. 2007. A comparison of single oxidants versus advanced oxidation processes as chlorine-alternatives for wild blueberry processing (Vaccinium angustifolium) International Journal of Food Microbiology. 116:25-31.
Referencias
Amat, A. M., Arques, A., Miranda, M. A. y López, F. 2005. Use of ozone and/or UV in the treatment of effluents from board paper Industry. Chemosphere. 60(8):1111-1117.
Anipsitakis, G. y Dionysiou, D. D. 2003. Degradation of organic contaminants in water with sulfate radicals generated by the conjunction of peroximonosulfate with cobalt. Environmental Science and Technology. 37:4790-4797.
Bankian-Tabrizi, G. y Mehrvar, M. 2004. Integration of advanced oxidation technologies and biological processes: Recent developments, trends, and advances. Journal of Environmental Science and Health. Part A-Toxic/Hazardous Substances & Environmental Engineering. A39:(11-12) 3029-3081
Bandala, E. R., Domínguez, F., Rivas, F. y Gelover, S. 2007. Degradation of atrazine using solar driven
Cho, M. Choi, Y., Park, H., Kim, K., Woo G-J. y Park, J. 2007. Titanium Dioxide/UV Photocatalytic Disinfection in Fresh Carrots. Journal of Food Protection. 70(1):97-101.
Cho, M. y Yoon, J. 2008. Measurement of OH radical CT for inactivating Cryptosporidium parvum using photo/ferrioxlate and photo/TiO2 systems. Journal of Applied Microbiology. 104: 759-766.
Domenech, X., Jardim W. F. y Litter, M. I. 2004. Procesos avanzados de oxidación para la remoción de contaminantes. En: Blesa M.A., Sánchez B. (Eds.) Remoción de contaminantes por fotocatálisis heterogénea. Editorial CIEMAT, Madrid, España.
Garret, E. 2002. Fresh-cut produce: Tracks and trends. En “Fresh-cut fruits an vegetables Science, Techology, and Market”. Ed. O., Lamikanra. P.1. CRC Press. Boca Raton. Florida. EE.UU.
Gil del Valle, L., Martínez-Sánchez, G., GonzálezBlanco, I. y Pérez-Avila, L. 1999. Estrés oxidativo: Mecanismos generales involucrados y su relación
con el virus de la inmunodeficiencia humana. Bioquímica. 24:85-92.
Glaze, W. H. 1987. Drinking water treatment with ozone. Environmental Science and Technology 21:224-230.
Guisar, R., Herrera, M. I., Bandala, E. R., García, J. y Corona B. 2007. Inactivation of waterborne pathogens using solar photocatalysis. Journal of Advanced Oxidation Technologies. 10(2):1-4.
Herney-Ramírez, J., Lampines, M., Vivente, M. A., Costa, C. A. y Medeira, L. M. 2008. Experimental design to optimize the oxidation of orange II dye solution using a clay-based Fenton-like catalyst. Industrial Engineering Chemistry Research. 47(2):284-294.
Kim, Y., Choi, S., Park, J., Chung, M., Song, K., Hwang, I., Known, K. y Park, K. 2009. Disinfection of iceberg lettuce by titanium dioxide–UV photocatalytic reaction. Journal of Food Protection. 72(9):1916-1922.
Kim, J. Y., Lee, Ch., Sedlak, D. L., Yoon, J. y Nelson, K. L. 2010. Inactivation of MS2 coliphage by Fenton’s reagent. Water Research. 44:2647-2653.
Lonnen, J., Kilvington, S., Kehoe, S. C., Al-Touati, F. y McGuigan. 2005. Solar and photocatalytic disinfection of protozoan, fungal and bacterial microbes in drinking water. Water Research 39:877-883.
Mittler, R. 2002. Oxidative stress, antioxidants and stress tolerance. Trends in Plant Science. 7(9):405410.
Muranyi, P., Schraml, C. y Wunderlich, J. 2010. Antimicrobial efficiency of titanium dioxide-coated surfaces. Journal of Applied Microbiology 108:1966-1973.
Parish, M. E., Beuchat, L. R., Suslow, T. V., Harris, L. J., Garrett, E. H., Farber, J. N. y Busta, F. F. 2003. Methods to Reduce/Eliminate Pathogens Fresh-Cut Produce. Comprehensive Reviews in Food Science and Food Safety. 2 (Suplemento)161-73.
Pera-Titus, M., García-Molina, V., Baños, M. A., Giménez, J. y Esplugas, S. 2004. Degradation of chlorophenols by means of advanced oxidation processes: a general review. Applied Catalysis B: Environmental. 47(4):219-256.
Rivera, S. P., Flóres, L. J. y Sanabria, J. 2010. Standardization of a quantification method for Salmonella spp. and Shigella spp. in specific liquid media. Colombia médica. 41(1):60-70.
Rodríguez, M., Hernández, A. y Peralta, J. M. 2010. Generación de especies oxidantes por métodos homogéneos y heterogéneos. Ciencia UANL. 13(2):162-166.
Selma, M. V., Allende. A., López-Gálvez, F., Conesa, M. A. y Gil, M. I. 2008. Heterogeneous photocatalytic disinfection of wash waters from the fresh-cut vegetable industry. Journal of Food Protection. 71(2):286-292.
Sichel, C., De Cara, M., Tello, J., Blanco, J. y Fernández-Ibáñez. P. 2007. Solar photocatalytic disinfection of agricultural pathogenic fungi: Fusarium species. Applied Catalysis B: Environmental. 74:152-160.
Silva, A., Trujillo, S. A., Aguilar, J. e Hincapié, G. 2009. Tratamiento de contaminantes orgánicos por foto-Fenton con luz artificial. Revista Ingenierías Universidad de Medellín. 8(15):53-62.
Srinivasan, C. y Somasundaram, N. 2003. Bactericidal and detoxification effects of irradiated semiconductor catalyst, TiO2. Current Science 85(10):1431-1438.
Swindle, E. y Metcalfe, D. 2007. The role of reactive oxygen species and nitric oxide in mast cell dependent inflammatory processes. Immunological Reviews. 217:186-205.
Wang, L., Gong, L., Zhao, E., Yu, Z., Torimoto, Y., Sadakata, M. y Li, Q. X. 2007. Inactivation of Escherichia coli by O- water. Letters in Applied Microbiology. 45:200-205.
Zhou, H. y Smith, D. W. 2002. Advanced technologies in water and wastewater treatment. Canadian Journal of Civil Engineering. 1: 247-264.

Temas Selectos de Ingeniería de Alimentos 5 – 1 (2011): 32 - 40

Mostaza: características químicas, botánicas y sus aplicaciones en el área de alimentos
B. Mejía-Garibay*, A. López-Malo, J.A. Guerrero-Beltrán
Departamento de Ingeniería Química, Alimentos y Ambiental, Fundación Universidad de las Américas Puebla. Exhacienda Sta. Catarina Mártir S/N, Cholula, Puebla. C.P.72810. México.
Resumen
Las especias son materiales vegetales con usos tan diversos tales como conservantes, colorantes y aromatizantes de los alimentos; algunas tienen la capacidad de estimular fuertemente el paladar. Entre éstas se encuentra la mostaza con características de sabor, color y aroma inigualables. La mostaza fue uno de los primeros cultivos domesticados por el hombre y se ha empleado en el área de alimentos y medicina desde tiempos muy antiguos. Existen tres principales variedades de mostaza: negra (Brassica nigra), blanca o amarilla (Brassica alba) y parda (Brassica juncea). La ventaja de estas variedades de mostaza es que se aprovechan tanto las hojas como las semillas para condimentar alimentos. En la actualidad, el consumo de la mostaza se ha incrementado debido a que, en investigaciones recientes se ha descubierto que tiene una alta efectividad antimicrobiana y antioxidante en los alimentos, además de propiedades medicinales. El objetivo de este trabajo es proporcionar una revisión actualizada de las características químicas y botánicas de la mostaza, así como sus aplicaciones.
Palabras clave: mostaza; características químicas; aplicaciones de la mostaza.
Abstract
Spices are plant materials with diverse applications such as food preservatives, coloring and flavoring agents. Some spices are able to strongly stimulate taste. Among these, mustard has unique flavor characteristics, color, and aroma. Mustard was one of the first domesticated crops and has been used in food and medicine since ancient times. There are three main types of mustard: black (Brassica nigra), white or yellow (Brassica alba), and brown (Brassica juncea). The advantage of these mustard varieties is that both leaves and seeds are used to flavor foods. Nowadays, consumption of mustard has increased due to recent research findings that demonstrate it is a highly effective antimicrobial and antioxidant in foods, as well due to its medicinal properties. The aim of this paper is to provide an updated review of the chemical and botanical characteristics of mustard and its applications.
Keywords: mustard; chemical characteristics; mustard applications.
*Programa de Doctorado en Ciencia de Alimentos
Tel: +52 222 229 2126, fax: +52 222 229 2727
Dirección electrónica: beatriz.mejia@udlap.mx
Introducción
La mostaza es una de las especias que desde tiempos muy antiguos ha sido usada como fuente de aceite comestible y en el área de medicina como antídoto en picaduras de escorpión y mordidas de víboras. Actualmente las semillas y las hojas se cosechan para propósitos medicinales, alimenticios y ciertas aplicaciones agrícolas. La mostaza se define como el producto resultante de la molienda de las semillas.
Esta especia ocupa el tercer lugar como el condimento más importante después de la sal y la pimienta. Mientras que las semillas enteras y su polvo seco carecen de aroma y sabor, éstos aparecen en presencia de agua o de líquidos poco ácidos (leche, cerveza). Es entonces cuando la enzima mirosinasa libera, a partir del glucósido sinagrina de las variedades de Brassica, el isotiocianato de alilo, esencia volátil de olor y sabor pungente (SchmidtHebbel, 2002).
En la segunda mitad del siglo XX el consumo mundial de la mostaza se incrementó de 75,000 a 170,000 toneladas. Originalmente la mayoría de los países aumentaron sus propios suministros, pero en el siglo XXI el proveedor predominante ha sido Canadá. Actualmente se ha desarrollado una fuerte demanda para la mostaza amarilla debido a su alto contenido de proteína y propiedades emulgentes y estabilizantes (Mc New y Bixley, 2001).
En la actualidad esta especia tiene aplicación en áreas como medicina y agricultura, debido a que se le han atribuido efectos anti-cancerígenos, propiedades antioxidantes y antibióticos de amplio espectro (King y Young, 2000), así como efectividad como fungicida (Mayton, 2006).
Dada la importancia de la mostaza, el objetivo de este trabajo es proporcionar una
revisión actualizada de sus características químicas y botánicas, así como de sus aplicaciones.
Revisión bibliográfica
1. Generalidades de la mostaza
De acuerdo a registros en Sánscrito que datan de alrededor del año 3000 A.C. (Mehra,1968) la mostaza es una de las especias más antiguas y uno de los primeros cultivos domesticados. Originalmente fue un condimento conocido como mostaza y su nombre se deriva del latín mustum. Se cree que fueron los romanos quienes desarrollaron el preparado de mostaza conocido hasta hoy. Mezclaban jugo de uva sin fermentar conocido como “mosto” con semillas de mostaza, para formar el mustum ardens o mosto ardiente. Los romanos dieron a conocer por toda Europa este condimento y empezó a ser popular para sazonar carne y pescado. Aparte de ser usada como condimento, el valor medicinal de la mostaza ya era conocido y mencionado por Pitágoras en el año 530 A.C., señalando que podía usarse como un remedio para las picaduras de escorpión. Se menciona también que la mostaza era usada como aromatizante para disfrazar el olor desagradable de alimentos perecederos (Thomas et al., 2004).
La mayoría de la mostaza se preparaba moliendo las semillas en un mortero y humedeciéndola con vinagre. En Dijon, Francia, se produjo una famosa mostaza en la que se empleaba verjus, un jugo ácido extraído de uva blanca de la región de Borgoña. La era moderna de la mostaza, comenzó en 1720 cuando el Sr. Clements de Durham en Inglaterra, encontró la manera de moler el corazón de las semillas y convertirlas en una harina fina. Otros empresarios experimentaron combinando varios tipos de semillas de mostaza para crear excelentes polvos de
mostaza. Hoy en día existen innumerables tipos de recetas de mostaza disponibles por el mundo, cada una reflejando la cocina local, regional y nacional (Thomas et al., 2004).
La mostaza es el condimento que posee mayor contenido de proteína (Tabla I) debido a su intensidad de sabor, la ingesta es mínima y su aporte es de 10 calorías por cada 2 gramos de ésta (Lund et al., 2000), por lo que su consumo se prefiere en lugar de aderezos como la mayonesa y la cátsup.
2. Especies principales
Las mostazas son miembros de las familias Cruciferaceae o Brassicaceae. El género Brassica consiste de 150 especies de hierbas anuales o bienales, algunas de las cuales son cultivadas para ser usadas como semillas oleaginosas o como forraje (Parry, 2002).
Tres especies de mostaza se cultivan por sus semillas: negra (Brassica nigra), blanca o amarilla (Brassica alba) y parda (Brassica juncea). Las tres contienen una cantidad significativa de aceite comestible y proteína de alta calidad.
Brassica alba (L.) sinónimo Sinapsis alba (L) o B. hirta. Ésta es comúnmente llamada
mostaza amarilla. Es originaria del sureste de Europa. Actualmente es cultivada en Australia, China, Chile, Japón, Inglaterra, Canadá y Estados Unidos (Farrell, 2000). Es una planta herbácea anual. Sus hojas son largas, erizadas, dentadas y con vellosidades de ambos lados. Las flores son pequeñas, amarillas, de cuatro pétalos, cruciformes con pistilo bicarpelado. Las frutas son silicuas erizadas esféricas, ensiformadas con largos picos. Las semillas son globulares y amarillentas, de 1.5 a 3 mm de diámetro (Parry, 2002).
La mostaza blanca o amarilla contiene el glucosinolato sinalbina (Fig. 1), que por la hidrólisis causada por la enzima mirosinasa produce compuestos como p-hidroxibencilisotiocianato, p-hidroxibencilamina, conocidos como “los principios blancos” y otros compuestos similares (proteínas, aceites, mucílago). Los isotiocianatos son los principales ingredientes de la mostaza blanca o amarilla (Antol y Levenson, 2000). El phidroxibencil isotiocianato está asociado exclusivamente con la semilla de mostaza amarilla. Este compuesto es un sólido inestable no volátil, su inestabilidad se atribuye a que el grupo p-hidroxibencil puede formar fácilmente una quinona inestable como intermediario (Isshiki et al., 2002).
ComposiciónSemilla de mostazaPolvo de mostazaAceite de mostaza Agua (g)6.863.00
(g)4.514.00
Adaptado de Thomas et al. (2004)
Tabla I. Composición nutrimental de semillas, polvo y aceite de mostaza (por 100 g).

Brassica juncea (L.) ó mostaza parda fue introducida originalmente de China al noreste de la India de donde se ha extendido a Afganistan via Punjab (Sambamurthy y Subrahmanyam, 2000). Ésta es popularmente conocida como rai ó mostaza de la India. La mostaza parda comprende dos tipos, la “Oriental”, la cuál es usada más comúnmente por los chinos, y la otra variedad más oscura que es usada por los indios. Las flores son pequeñas y de un color amarillo brillante. Las semillas son pequeñas y contienen 35% de aceite (Parry, 2002).
Los constituyentes más importantes en la mostaza parda, son los glucosinolatos y sinagrina (Fig. 1), la enzima mirosinasa, ácido sinapico, sinapina, y aceites constituidos principalmente de glicéridos de ácido erúcico, eicosenoico, araquídico, nonadecanoico, behénico, oleico y palmítico (Leung y Foster, 2006). La sinagrina, en la hidrólisis causada por la enzima mirosinasa, produce alilisotiocianato, glucosa y bisulfato de potasio. El alilisotiocianato es un componente
volátil producto principalmente de B. juncea Cantidades menores de componentes volátiles, que también son liberados por la hidrólisis, incluyen los siguientes: metil, isopropil, secbutil, butil, 3-butenil, 4-pentenil, fenil-3metilpropil y beta-feniletilisotiocianatos (Hanley et al., 2002).
Brassica nigra (L.) ó mostaza negra también es nombrada mostaza real. La mostaza negra es probablemente endémica del sureste de la región del Mediterráneo. Brassica nigra es de importancia no sólo como una planta de cultivo sino que también ha contribuido a la evolución de varias especies del género Brassica. Esta planta alcanza una altura de 1 m. Las hojas son pecioladas de color verde oscuro. Las flores son pequeñas de color amarillo brillante, cruciformes con cuatro pétalos. Las frutas son cápsulas cuadrangulares, suaves con un pico delgado corto. Las semillas son pequeñas, de color rojizo a negro, su diámetro es de 2 mm o menos (Uhl, 2000).
La mostaza negra contiene constituyentes similares a B. juncea, predominantemente sinagrina, que en la hidrólisis produce alilisotiocianato.
3. Aplicaciones de la mostaza
Las mostazas son un grupo versátil de plantas. Las hojas, semillas y aceite pueden usarse en una variedad de formas (Thomas et al., 2004).
Las hojas de mostaza ya sean tiernas ó verdes, así como las vainas verdes, se consumen como verduras o ensaladas. Las hojas tiernas deshidratadas o secas están disponibles en el mercado como verduras (Pruthi, 2001).
Las semillas de mostaza han sido usadas como especias y medicamentos desde tiempos inmemorables. Han sido incorporadas en varios alimentos como salsas, cremas, curris y encurtidos. Las semillas se pueden usar para dar y potenciar el sabor de algunos alimentos (Dunn, 2010), y actúan como conservadores contra la acción de mohos y levaduras. En la industria del vino, han sido usadas para remover y evitar la presencia de mohos en el vino y en los barriles (Thomas et al., 2004). Las semillas de mostaza trituradas se utilizan principalmente para dar apariencia y textura a los aderezos. En muchos países se usan como aglutinante natural en lugar de los almidones y
gomas que contienen los productos a base de tomate (Dunn, 2010).
3.1 Aceite de mostaza
Los aceites son obtenidos por el prensado de las semillas y el subsecuentemente proceso de refinación para usarse en los alimentos. El aceite de mostaza es un líquido amarillo pálido y es usado para propósitos comestibles. En la mostaza negra y blanca se obtiene del 24 al 40% de aceite. Las semillas de mostaza contienen antioxidantes naturales que protegen al aceite de la rancidez. Una porción de esta protección es proporcionada por los tocoferoles (Luthy y Matile, 2004).
Los aceites de mostaza son también llamados “aceites de ácido erúcico” debido a su alto contenido de este ácido (FAO, 2001). Otros ácidos grasos presentes en el aceite de mostaza son ácidos grasos insaturados como oleico, linolénico y ácidos saturados como behénico, esteárico, mirístico y lignocérico (Sindhu et al., 2003). La composición típica de ácidos grasos en las diferentes variedades de mostaza se muestra en la Tabla II. Como se observa los ácidos oleico, linolénico y linoleico se encuentran en un alto porcentaje. Estos ácidos poseen múltiples beneficios y usos. En muchos estudios se ha demostrado que el ácido oleico y linoleico ejercen una acción beneficiosa en los
Ácidos grasosMostaza Amarilla Mostaza Cáfe Palmítico (%)3.33.6
Esteárico (%)0.80.8
Oleico (%)1719
Linoleico (%)1223
Linolénico (%)1515
Eicosenoico (%)912
Erúcico (%)4021
Fuente: Voroëv (2000).
Tabla II. Composición de ácidos grasos de los aceites de mostaza amarilla (B.alba) y café (B. juncea).
vasos sanguíneos reduciendo el riegos de sufrir enfermedades cardiovasculares (Renaud y Lanzmann-Petithory, 2002). Así mismo, la presencia de ácido linolénico confiere a los aceites en los que se encuentra propiedades tecnológicas únicas para su empleo en formulaciones comerciales de tintas, barnices, pinturas y lacas entre otros. Los aceites ricos en ácido linolénico tiene una amplia gama de aplicaciones como materia prima renovable en la industria química (Overeem, 2000).
El aceite de mostaza se usa como aceite comestible y también en la manufactura de aderezos, margarina y mantecas vegetales. El aceite refinado se utiliza en la industria como lubricante para superficies de metales, en el engrasado y como plastificantes, entre otros usos (Leung y Foster, 2006). Para confirmar la identidad y comestibilidad de un aceite, es necesario realizar el análisis de sus características físicas y químicas, ya que de ellas derivan sus propiedades.
En un análisis de rutina las determinaciones de los índices de yodo, saponificación y la materia saponificable, son suficientes para este propósito. Como se observa en la Tabla III, el índice de yodo para el aceite de B. nigra es mayor que el de los aceites de B. juncea y B.
alba, lo cual indica mayor contenido de ácidos grasos insaturados. Esta misma variedad presenta mayor índice de saponificación, isotiocianatos y cianuros.
El olor característico del aceite de mostaza es producido por el sulfuro obtenido por la hidrólisis de los glucósidos contenidos en la semilla y trazas de alilisotiocianato, el cual confiere un olor desagradable a la mostaza (Whitmore y Naidu, 2000).
3.2 Mostaza molida, harina y preparado.
Algunos de los productos comerciales de la mostaza son harina de mostaza, mostaza molida y el preparado de mostaza. La harina de mostaza es un polvo fino obtenido de la porción interior de las semillas. Es considerada como un ingrediente para mayonesas, aderezos, salsas y productos relacionados. La harina de mostaza tiene propiedades de conservador y antioxidante, además de proveer sabor y color. Se encontró que es más potente que dos conservadores químicos conocidos como ácido benzoico y dióxido de azufre (Pruthi, 2002). En los aderezos para ensaladas, la propiedad más importante de esta especia es su capacidad como emulgente, pues une las fases agua-aceite e incrementa la viscosidad (Uhl, 2000).
Datos
B. junceaB. nigraB. alba
Aceite extraído por éter de petróleo (%)40.438.846.2
Ácidos grasos libres (%)3.83.92.6
Glicéridos (%)92.292.193.1
Materia insaponificable (%)1.10.90.8
Isotiocianatos (%)0.580.80.28 Cianuro (%)0.030.040.02
Indice de saponificación (mg KOH / g)174175172
Indice de yodo (cg I2 /g)10310895
Fuente: López et al. (1999)
Tabla III. Valores químicos de los aceites de las principales especies de mostaza.
La mostaza molida es un polvo obtenido por molienda de semillas de mostaza amarilla y es ampliamente usada en la industria de cárnicos como emulgente, ligante de agua y agente texturizante. Una nueva forma de presentación de la mostaza molida es como mostaza desactivada. La desactivación se realiza sobre la enzima mirosinasa, al exponerla a condiciones de calor y humedad controladas, con este proceso se logra eliminar la pungencia de sabor. La mostaza desactivada se utiliza para facilitar el rebanado de quesos procesados y mejorar su estabilidad frente al calor. Además es un ingrediente indispensable en la industria panadera, debido a que mejora el sabor, la absorción del agua, la matriz de gluten, relaja la masa y mejora su elasticidad (Dunn, 2010).
El preparado de mostaza es una pasta elaborada de semillas de mostaza, vinagres, especias y cúrcuma (Charalambous, 2004).
ciclos logarítmicos de ambos patógenos (ChiaMin et al., 2000).
Nielsen y Ríos (2000) demostraron la efectividad anti-fúngica del alilisotiocianato sobre mohos y levaduras en pan de centeno y otras variedades de productos de panificación. Los microorganismos analizados en este experimento fueron Aspergillus flavus, Endomyces fibuliger, Penicillium commune, Penicillium corylophilum, Penicillium discolor, Penicillium palitans, Penicillium roqueforti, Penicillium solitum y Pichia anomala. Los resultados obtenidos mostraron que la actividad fungicida y fungistática dependía de la concentración de los componentes volátiles del aceite.
Conclusiones
3.3. Aceite esencial de mostaza
Otro producto que se ha extraído a partir de las semillas es el aceite esencial, el cual contiene principalmente alilisotiocianato, se ha investigado que este compuesto tiene un gran efecto inhibitorio y posee una amplia actividad antimicrobiana contra una gran variedad de bacterias como E. coli 33625, E. coli NC101, Pseudomonas fluorescens, Staphylococcus aureus 4220, Bacillus subtilis IS75, Lactobacillus brevis MD42 y algunas levaduras como Saccharomyces cerevisiae MD7, Pichia membranefaciens Y1617 y Torulopsos etchellsii Y6651 (Shofran et al., 2000; Brabban y Edwards, 2001).
En otras investigaciones se ha empleado el vapor del alilisotiocianato obtenido a partir del aceite esencial, en lechugas frescas inoculadas con Escherichia coli O157:H7 y Listeria monocytogenes; logrando una reducción de 8
En base a la revisión realizada se observa que existen diferencias entre las características químicas y botánicas de las tres principales especies de mostaza, estas diferencias en la composición a partir de hidrólisis enzimática permiten la formación y liberación de otros compuestos como proteínas, aceites, entre otros, que permiten su aplicación en diferentes áreas.
En la actualidad a partir de investigaciones sobre la composición química de la mostaza, se han logrado importantes avances en su posible aplicación en diferentes áreas como alimentos, medicina y agricultura. Las investigaciones más recientes se han enfocado en el área de alimentos, donde se ha evaluado su potencial uso como agentes antimicrobianos o emulgentes. Actualmente también se emplea como mostaza desactivada para elaborar quesos procesados y productos de panadería. Debido a sus propiedades antioxidantes, la mostaza está ganando terreno en comparación con otras especias; sin embargo, se continúan realizando investigaciones sobre sus
propiedades funcionales y otras áreas de aplicación que podría tener esta especia.
Agradecimientos
A la Universidad de las Américas Puebla y al Consejo Nacional de Ciencia y Tecnología (CONACyT, México) por el financiamiento recibido para la realización de este trabajo.
Referencias
Antol, M.N.y Levenson, B. 2000. The incredible secrets of Mustard: The Quintessential Guide to the History, Lore, Varieties and Healthful Benefits of Mustard. Avery Publishing Group. 21 p.
Brabban, A.D., y Edwards, C. 2001. Isolation of glucosinolate degrading microorganisms and their potencial for reducing the glucosinolate content of rapemeal. Federation of European Microbiological Societies Letters. 119:83-88.
Charalambous, G. 2004. Off-Flavor in Foods and Beverages. Developments in Food Science series 34. Elsevier Science B.V., Amsterdam, The Netherlands. 265 p.
Chia-Min, L., Jeongmok, K., Wen-Xian, D.y Cheng-I, W. 2000. Bactericidal Activity of Isothiocyanate against Pathogens on Fresh Produce. Journal of Food Protection. 63(1):25-30.
Dunn,G.S. 2010. Mostaza una opción natural. http://www.gsdunn.com/es/contact-us. Accesada: 16/03/2011.
FAO. 2001. “Utilización de alimentos tropicales: semillas oleaginosas tropicales”. Ed. Roma. El Salvador. San Salvador. 92p.
Farrell, K.T. 2000. Spices, Condiments and Seasonings. AVI Publishing Co., Westport, Connecticut. 150 p.
Hanley, B.A., Parsley, K.R., Lewis, J.A. y Fenwick, R.G. 2002. Chemistry of indole glusosinolates: Intermediacy of indole methyl isothiocyanates in the enzyme hydrolysis of indol glucosinolates. Journal Chemical Societies Perkin Trans. 1:2273-2276.
Isshiki, K., Tokuoka, K., Mori, R. y Chiba, S.J. 2002. Preliminary examination of allyl isothiocyanate vapor for food preservation. Bioscience Biotechnology and Biochemistry. 56: 1476-1477.
King, A. y Young G. 2000. Characteristics and occurrence of phenolic phytochemicals. Journal of the American Dietetic Association. 99 (2):214.
Leung, A.Y. y Foster, S. 2006. “Encyclopedia of Common Natural Ingredients Used in Food, Drugs and Cosmetics”. Segunda edición. John Wiley and Sons, Inc. New York. E.E.UU. 649 p.
López, E., Vázquez, B. y Bosch, B. 1999. Grasas y Aceites. 50:444-447.
Lund, B., Baird-Parker, T. y Gould, G. 2000. “ Safety and Quality of Food”.Vol. II. Aspen Publishers, Inc. Maryland. EE.UU. 1882 p.
Luthy, B. y Matile, P. 2004. The mustard oil: Rectified analysis of subcellular organization of the myrosinase system. Biochemistry Physiology Pflanzen.179:5-12.
Mayton, H.S. 2006. Correlation of fungicidal activity of Brassica species with allyl isothiocyanate production in macerated leaf tissue. Phytopathology. 86:267271.
McNew, K. y Bixley, S. 2001. Mustard: Production, Uses, and Exports. Agricultural Marketing Policy Center. Briefing No. 21.
Mehra, K.L. 1968. History and ethnobotany of mustard in India. Advancing Frontiers of Plant Sciences. 19:57.
Nielsen, V.P. y Rios, R. 2000. Inhibition of fungal growth on bread by volatile components from spices and herbs, and the possible application in active packaging, with special emphasis on mustard essential oil. International Journal of Food Microbiology. 60:219-229.
Overeem, A. 2000. Seed oils rich in linolenic acid as renewable feedstock for environment-friendly crosslinkers in powder coatings. Industrial Crops and Products. 10:157-165.
Parry, J.W. 2002. “Spices: Morphology, Histology and Chemistry”.Vol. I y II. Chemical Publishing Co. New York. EE.UU. 249 p. 360 p.
Pruthi, J.S. 2002. “Spices and Condiments”. National Book Trust of India. New Delhi. India. 414 p.
Pruthi, J.S.2001. “Minor Spices and Condiments- Crop Management and Post Harvest Technology”.
Directorate of Information and Publication of Agriculture. New Delhi. India. 782 p.
Renaud, S. y Lanzmann-Petithory, D. 2002. Dietary Fast and Coronary Heart Disease Patogenesis. Current Atherosclerosis Reports. 4:410-424.
Sambamurthy, A.V.S.S y Subrahmanyam, N.S. 2000.”Economic Botany of Crop Plants”. Asitec Publishers Ltd, New Delhi. India. 424 p.
Schmidt-Hebbel, H. 2002. “Las especias (Condimentos vegetales) Su importancia en Química y tecnología de los alimentos y en el arte culinario”. Editorial Universitaria. Santiago. Chile. 108 p.
Shofran, B.G., Purrngton, S.T., Breidt, F. y Fleming, H.P. 2000. Antimicrobial properties of sinigrin and its hydrolysis products. J. Food Sci. 63:621-624.
Sindhu, K. T.C., Nagaraju, T. y Kantharas, U.K. 2003. Glucosinolate and lipid composition of newer indian
varieties of mustard and rapessed. Journal Food Science Technology. 30: 137-138.
Tainter, D.R. y Grenis, A.T. 2001. “Spices and Seasoning: A Food Technology Handbook”. Second edition. John Wiley and Sons Inc. New York. EE.UU. 249 p.
Thomas, K., Kuruvilla, M. y Hrideek, T.K. 2004. Mustard. En “ Handbook of Herbs and Spices”. Vol 2. Ed. K.V. Peter.198. CRC Press. Boca Raton. Fla. EE.UU. 360 p.
Uhl, S.R. 2000. “Handbook of Spices, Seasonings and Flavourings”. Technomic. Publishing Co. Inc. Lancaster. EE.UU. 329 p.
Voroëv. 2000. Fatty acids in some varieties of Indian mustard. Maslozhir Prom. 32: 10-12.
Whitmore, B.B. y Naidu, A.S. 2000. Glucosinolates. Chemical abstracts 137:399-416.

Temas Selectos de Ingeniería de Alimentos 5 – 1 (2011): 41 - 50

Actividad antimicrobiana de aceite esencial de tomillo
(Thymus vulgaris)
A. Rosas-Gallo* y A. López-Malo
Departamento de Ingeniería Química, Alimentos y Ambiental, Fundación Universidad de las Américas Puebla. Exhacienda Sta. Catarina Mártir S/N, Cholula, Puebla. C.P.72810. México.
Resumen
El uso de agentes químicos, especialmente los llamados agentes antimicrobianos, es parte de los métodos de conservación más antiguos y tradicionales que existen. Sin embargo, la incorporación de estos agentes a los alimentos evita que estos cumplan con el concepto de natural o “libre de conservadores” que los consumidores demandan actualmente. Por lo que en la presente revisión se explica la importancia de la actividad antimicrobiana de los aceites esenciales, principalmente del aceite esencial de tomillo, como posible fuente de compuestos antimicrobianos naturales.
Palabras clave: tomillo, aceites esenciales, compuestos fenólicos, carvacrol, timol.
Abstract
The use of chemical agents, especially those known as antimicrobial agents, are among the oldest and traditional preservation methods utilized. However, their incorporation into food does not meet the concept of natural or "preservative free” that consumers demand. This review explains the importance of the antimicrobial activity of essential oils, as possible sources of natural antimicrobials.
Keywords: thyme, essential oils, phenol compounds carvacrol, thymol.
Introducción
Giese (1994) menciona que la seguridad de los alimentos se incrementa y asegura por el uso de compuestos llamados antimicrobianos, ya que estas sustancias se añaden a los alimentos para prevenir y detener la descomposición microbiana. La manera más importante de pérdida de la
*Programa de Maestría en Ciencia de Alimentos
Tel.: +52 222 229 2126, fax: +52 222 229 2727
Dirección electrónica: anabel.rosasgo@udlap.mx
calidad en alimentos, es aquella asociada con el deterioro microbiano y en particular con la presencia y/o crecimiento de microorganismos patógenos. Esto ha llevado a investigar el uso y modo de acción de los conservadores disponibles a fin de emplearlos más eficientemente y a estudiar su aplicación al combinarlos con otras formas tradicionales y no tradicionales de preservación. Las formas conocidas de combatir los efectos deteriorativos de los microorganismos en alimentos incluyen: la prevención de su acceso a los alimentos, la
inactivación de los mismos y la disminución o inhibición de su crecimiento (Gould y Russell, 1991). Los agentes antimicrobianos pueden ser compuestos sintéticos adicionados intencionalmente a los alimentos o compuestos naturales que son sustancias de origen biológico (también denominados antimicrobianos naturales) y que pueden usarse comercialmente como aditivos para conservar alimentos.
Una amplia variedad de antimicrobianos naturales han sido obtenidos a partir de microorganismos, animales y plantas. Un gran número de ellos ya son empleados para la conservación de alimentos, mientras que muchos otros están siendo estudiados.
Entre los antimicrobianos naturales más estudiados se encuentran los presentes en plantas, las hierbas y especias. En la Tabla I se listan algunas de las especias, hierbas y plantas que se han estudiado como posibles fuentes de antimicrobianos. Se reconoce que los componentes activos en muchas plantas, hierbas y especias son compuestos fenólicos y aceites esenciales. De acuerdo con Shelef (1983), los compuestos fenólicos son probablemente los componentes antimicrobianos mayoritarios presentes en los aceites esenciales de especias. El uso de aceites esenciales extraídos de diferentes frutos cítricos o plantas aromáticas, ha sido muy estudiado, y se ha comprobado que estas sustancias en combinación con otros agentes de estrés microbiano dan mejor resultado en la conservación de los alimentos, que el uso de antimicrobianos tradicionales por sí solos.
Se ha reportado que algunos de éstos compuestos fenólicos tienen un amplio espectro de efectividad contra los microorganismos, como el timol extraído del tomillo y del orégano, el aldehido cinámico extraído de la canela y el eugenol extraído de clavos. La vainillina, compuesto presente en
las vainas de la vainilla, es estructuralmente similar al eugenol y tiene también actividad antimicótica (Beuchat y Golden, 1989; López-Malo et al., 2005). En general se reporta que la actividad antimicrobiana de los aceites esenciales depende de la estructura química de sus componentes, especialmente se reconoce que los alcoholes alifáticos y fenoles exhiben acción inhibitoria para el crecimiento de hongos (Farag et al., 1989; López-Malo et al., 2005).
En investigaciones recientes se ha demostrado que el aceite esencial de tomillo tiene compuestos fenólicos entre los cuales están el timol, anetol y boneol en las hojas y carvacrol y anetol en toda la planta (Baltazar, 2003).
Por lo anterior, en este trabajo se revisarán aspectos sobre los usos de aceites esenciales como agentes antimicrobianos naturales, haciendo énfasis en el aceite esencial de tomillo.
Revisión bibliográfica
1. Agentes antimicrobianos
Anteriormente se utilizaban algunos tipos de agentes que parecían útiles para la conservación de los alimentos; ya que se notaba que al agregarlos, el alimento duraba más tiempo, ejemplo de ello es la sal común, y ésta se ha utilizado para preservar alimentos tales como carne, pescados, mariscos, frutas y otros productos.
Con el paso de los años y las investigaciones se ha llegado a saber que la velocidad de deterioro microbiano en alimentos no solo depende de los microorganismos presentes, sino también de
Tabla I. Algunas especias, hierbas y condimentos evaluados como posibles antimicrobianos.
Albahaca (Basil)
Laurel (Bay)
Cilantro (Coriander)
Canela (Cinnamon)
Clavo (Clove)
Comino (Cumin)
Eneldo (Dill)
Hinojo (Fennel)
Ajo (Garlic)
Jenjibre (Ginger)
Te-limón (Lemongrass)
Mejorana (Marjoram)
Menta (Mint)
Mostaza (Mustad)
Cebolla (Onion)
Orégano (Oregano)
Perejil (Parsley)
Pimienta (Pepper)
Romero (Rosemary)
Tomillo (Thyme)
Vainilla (Vanilla)
la composición química del producto y de la carga microbiana inicial. Los antimicrobianos son compuestos químicos añadidos o presentes en los alimentos que retardan el crecimiento microbiano o inactivan a los microorganismos y por lo tanto detienen el deterioro de la calidad y mantienen la seguridad del alimento (Baltazar, 2003).
Muchos investigadores han llegado a la conclusión en que la evolución de aditivos para alimentos debe basarse en un balance entre los riesgos y beneficios (Baltazar, 2003), de esta manera en un futuro los aditivos benéficos serán aquellos que
Ocimum basilicum
Laurus nobilis
Coriandum sativum
Cinnamomum zeylanicum
Syzygium aromaticum
Cuminum cyminum
Anethum graveolens
Foeniculum vulgare
Allium sativum
Zingiber officinale
Cymbopogon citratus
Origanum majorana
Mentha vulgaris, M. spicata
Brassica hirta, B. juncea, B. nigra
Allium cepa
Origanum vulgare
Petroselinum crispum
Piper nigrum
Rosmarinus officinalis
Thymus vulgaris
Vanilla planifolia, V. pompona, V. tahilensis
contengan o cumplan con varias funciones, dependiendo del alimento al cual se añadan.
Actualmente se producen antimicrobianos en forma sintética, pero estos también se encuentran presentes en forma natural como componentes de diversos alimentos. De tal manera que los compuestos químicos de acción antimicrobiana y que se encuentran en los alimentos pueden clasificarse como aditivos tradicionales con acción directa o indirecta (Moreno, 2002).
1.2 Agentes antimicrobianos sintéticos
Uno de los factores que gobierna el crecimiento de los microorganismos en los
alimentos es el pH. En general las bacterias crecen a pH cercanos a la neutralidad (pH 6.5 a 7.5); sin embargo, son capaces de tolerar un rango de pH entre 4 y 9. A diferencia de éstas, los mohos y las levaduras toleran un rango más amplio de pH para su crecimiento, ya que pueden crecer a pH por debajo de 3.5. Las levaduras y mohos deteriorativos proliferan más comúnmente en frutas y vegetales debido a sus características inherentes como su bajo pH y baja capacidad reguladora (Monou et al., 1998). Una manera efectiva de limitar el crecimiento de los microorganismos es incrementar la acidez del alimento. La capacidad de limitar el crecimiento de los microorganismos dependerá del tipo de microorganismo, especie, tipo y concentración del ácido, tiempo de exposición y la capacidad reguladora del alimento.
La actividad de los ácidos orgánicos utilizados como agentes antimicrobianos es totalmente dependiente del pH y de la capacidad de disociación del ácido (pKa), ya que como se ha señalado la forma nodisociada del ácido es la responsable de la actividad antimicrobiana. En consecuencia al escoger un ácido orgánico como aditivo alimentario antimicrobiano, hay que tener en consideración tanto el pH del producto como el pKa del ácido.
El uso de ácidos orgánicos se restringe generalmente a alimentos con pH menor de 5.5, debido a que la mayor parte de los ácidos orgánicos tienen pKas entre 3.0 y 5.0 (Ultee et al., 2000). El modo de acción de los ácidos orgánicos utilizados como agentes antimicrobianos (sorbatos, benzoatos, propionatos), en la inhibición del crecimiento microbiano parece estar relacionado con el mantenimiento del equilibrio ácido-base, la donación de protones y la producción de energía por las células. Los sistemas biológicos y químicos
dependen de la interacción entre los sistemas ácido-base. La célula microbiana normalmente refleja este equilibrio atendiendo al mantenimiento de un pH interno cercano a la neutralidad.
La homeostasis es la tendencia de una célula a sostener un equilibrio químico a pesar de las fluctuaciones en el ambiente. Este balance se mantiene por medio de la interacción de una serie de mecanismos químicos, causando alteración y destrucción de las células microbianas. Las proteínas, los ácidos nucleicos y fosfolípidos pueden ser alterados estructuralmente por los cambios de pH (Dorman y Deans, 2000).
1.3 Antimicrobianos naturales
Muchos alimentos contienen compuestos naturales con actividad antimicrobiana. En estado natural, estos compuestos pueden desempeñar el papel de prolongadores de la vida útil de los alimentos. Incluso muchos de ellos han sido estudiados por su potencial como antimicrobianos alimentarios directos. El uso de aditivos alimentarios de origen natural implica el aislamiento, purificación, estabilización e incorporación de dichos compuestos con fines antimicrobianos a los alimentos sin que ello afecte negativamente a las características sensoriales, nutritivas y a su garantía sanitaria (Suhr y Nielsen, 2003). Esto tiene que lograrse manteniendo los costos de formulación, procesado o comercialización.
Los sistemas antimicrobianos naturales pueden clasificarse por su origen, de tal forma existen antimicrobianos de origen animal, vegetal o microbiano. El primero de estos grupos incluye proteínas, enzimas líticas tales como lisozima, hidrolasas tales como lipasas y proteasas (Dorman y Deans, 2000) y polisacáridos como el quitosano (Lambert et. al., 2001). El segundo grupo incluye compuestos fenólicos provenientes
de cortezas, tallos, hojas, flores, ácidos orgánicos presentes en frutos y fitoalexinas producidas en plantas (Baltazar 2003), mientras que el tercer grupo incluye compuestos producidos por microorganismos, como son los compuestos llamados bacteriocinas.
1.3.1 Antimicrobianos derivados de plantas
Matamoros (1998) menciona que aproximadamente 1389 plantas son un recurso potencial de compuestos antimicrobianos. Estos compuestos incluyen muchas sustancias de bajo peso molecular como fenólicos, fitoalexinas, entre muchos otros. Los compuestos fenólicos son los más predominantes en muchos de los extractos y aceites esenciales provenientes de plantas.
La Tabla II muestra un listado de constituyentes en algunos extractos y aceites esenciales de platas. Muchas hierbas y especias contienen aceites esenciales que son antimicrobianos, y cerca de 80 productos de origen vegetal que contienen altos niveles de estos tendrían uso potencial en alimentos por ejemplo clavo, ajo, cebolla, salvia, mostaza, vainilla y frutos cítricos, entre otros.
Entre los antimicrobianos naturales que en los últimos años han despertado el interés de los investigadores en la industria alimenticia se encuentran las especias, que son raíces, corteza, capullos, semillas o frutos de plantas aromáticas (Tabla I), las cuales son usadas para condimentar los alimentos (Carrillo, 1999).
Tabla II. Constituyentes de extractos y aceites esenciales de plantas.
Nombre común
Aldehído
Cinámico
Alil
Isotiocianato
Anetol
Carvacrol
p-cimeno
cineol
Citral
Cominal
Eugenol
Limonero, linatol
Otros nombres
3-fenilpropenal
Alil isotiocianato
p-propemilanniso, 1-metodix-4propenilbenceno
2-hidroxi-p.cimeno,isotimol p-alifenol
Isopropil-tolueno
Eucaliptol
3,7-dimetil-2-6, octadienal
Culminaldehido
p-isoplopil benzaldehído
4-alil-2-metoxifenol
3,7-dimetil-3-hidroxil,1,6-octadieno
Plantas o especie
Canela
Mostaza
Hinojo
Tomillo, albahaca, estragón
Tomillo
Laurel, romero
Té de limón
Comino
Clavo
Té de limón, albahaca
Adaptada de Zaika (1888), Beuchat y Goleen (1989), Nychas (1995) y Shelef(1983)
1.3.2 Modo de acción de los antimicrobianos naturales extraídos de plantas
Los aceites y extractos de plantas, principalmente de clavo, orégano, tomillo y algunos otros, presentan actividad inhibitoria contra ciertos microorganismos de importancia en alimentos (Beuchat y Golden 1989). Considerando el gran numero de diferentes grupos de compuestos químicos presentes en los aceites esenciales (Tabla II), es importante decir que su actividad antimicrobiana no se atribuye a un mecanismo especifico; sin embargo, existen algunos sitios de acción en la célula en donde pueden ocurrir los siguientes efectos: daño a la membrana citoplasmática, degradación de la pared celular, daño a las proteínas, filtración del contenido celular, coagulación del citoplasma y disminución de la fuerza motriz (Friedman et al., 2002).
Burt y Rainder (2003) señalaron que al exponer las células a concentraciones subletales de agentes antimicrobianos naturales (como carvacrol y timol), hay cambios en la concentración de los ácidos grasos de la membrana celular, presentándose un aumento de los ácidos grasos insaturados.
La estructura química de los componentes individuales de los aceites esenciales afecta su modo preciso de acción y su actividad antimicrobiana. La importancia de la presencia de los grupos hidroxilo en los compuestos fenólicos ha sido confirmada (Dorman y Deans, 2000). Hay estudios que demuestran los efectos antimicrobianos que ejercen los compuestos aromáticos sobre la membrana citoplasmática, alterando su estructura y por consiguiente su función. Por ejemplo, Farag et al. (1989) en estudios con E. coli observaron una disminución en el potencial de membrana al exponer las células microbianas a algunos compuestos aromáticos como eugenol y carvacrol. Suhr
y Nielsen (2003), reportaron al realizar estudios con timol, eugenol y triclocarbon (TCC), que los dos primeros agentes antimicrobianos presentaban efecto bactericida contra microorganismos Gram negativos y positivos, provocando daño en la membrana celular y salida de los componentes intracelulares, sin embargo, TCC no provoco efectos letales en las células.
Generalmente, el flujo de iones potasio es una señal temprana del daño a la membrana citoplasmática y es seguido por el flujo de los demás constituyentes citoplasmáticos (Ultee et al., 2002). La perdida de la permeabilidad de la membrana es identificada como causa de la muerte celular y depende de la hidrofobicidad de los solutos que cruzan la membrana y de la composición de la misma. El coeficiente de partición de los aceites esenciales en las membranas celulares es un determinante crucial para su efectividad, por lo que se esperan variaciones cuantitativas en la actividad de los agentes antimicrobianos contra diferentes bacterias (Lambert et al., 2001). Algunas investigaciones señalan que la perdida de la funcionalidad de la membrana es solo una parte de la explicación de la actividad antimicrobiana que presentan dichos agentes (Burt, 2004).
Los componentes de los aceites esenciales también parecen actuar sobre las proteínas de las células que se encuentran embebidas en la membrana citoplasmática. Las enzimas ATPasas que se encuentran localizadas en dicha membrana pueden ser alcanzadas por las moléculas lipidicas, viéndose afectada la regulación de energía y la síntesis de componentes estructurales (Friedman et al., 2002).
Los componentes de los aceites esenciales, básicamente timol, carvacrol y eugenol, los cuales son compuestos
fenólicos, poseen fuertes propiedades antimicrobianas contra diversos microorganismos de interés en alimentos (Lambert et al., 2001) y es razonable pensar que su mecanismo de acción es similar al de otros compuestos fenólicos, provocando desorden en la membrana citoplasmática, rompimiento de la fuerza motriz del protón, flujo de electrones y coagulación del contenido celular (Davidson y Branen, 1997). Además, a diferencia de muchos antibióticos, los constituyentes hidrofobicos de los aceites esenciales son capaces de entrar en el periplasma de las bacterias Gram negativas a través de las proteínas de la membrana externa (Lambert et al., 2001).
Conner y Beuchat (1984) señalaron que la actividad antimicrobiana de los aceites esenciales en levaduras se debe al daño ocasionado a algunos sistemas enzimáticos involucrados con la producción de energía y síntesis de componentes estructurales. Algunos compuestos fenólicos cruzan la membrana citoplasmática e interaccionan con proteínas y enzimas de membrana, causando un flujo opuesto de protones afectando la actividad celular.
2. Aceite esencial de tomillo
El aceite esencial de tomillo (1.0-2.5%) está constituido principalmente por fenoles monoterpénicos, como timol, carvacrol, pcimeno, γ-terpineno, limoneno, borneol y linalol. No obstante, se ha de tener en cuenta que la composición del aceite esencial es variable según la época y lugar de la cosecha, además de la bien conocida existencia de diferentes quimiotipos. Se conocen dos clases de aceite esencial de tomillo: aceite de tomillo rojo y aceite de tomillo blanco (Alzamora et al., 2000).
En su composición química destacan el aceite esencial y los flavonoides. Otros componentes también destacables son los
ácidos fenólicos derivados del ácido cinámico (ácidos cafeico y rosmarínico), triterpenos (ácidos ursólico y oleanólico), saponinas, taninos y un principio amargo (serpilina).
Numerosos estudios demostraron que el aceite esencial de tomillo es uno de los aceites esenciales más potente en relación con propiedades antimicrobianas (Manou et al., 1998). El timol y carvacrol fueron algunos de los componentes más activos contra múltiples patógenos transmitidos por los alimentos.
La propiedad antimicrobiana del extracto de tomillo está asociada por su carácter lipofílico a la acumulación en membranas y los subsecuentes eventos en la membrana como la pérdida de energía. El mecanismo por el cual los microorganismos son inhibidos por compuestos fenólicos incluye la sensibilización de la bicapa fosfolípida de la membrana celular, causando un incremento en la permeabilidad y pérdida de constituyentes celulares vitales o daño de las enzimas bacterianas. También se presume que la inhibición bacteriana por el aceite de tomillo se debe a su hidrofobicidad y a los puentes de hidrógeno de sus constituyentes fenólicos a proteínas de membrana, cambiando la permeabilidad y características de la membrana. (Chiasson et al., 2004).
Se presentan a continuación algunos reportes sobre la actividad antimicrobiana de los componentes principales del aceite esencial de tomillo, carvacrol, timol, cimeno y terpineno.
2.1.
Carvacrol y timol
El timol y el carvacrol, son compuestos fenólicos que son similares estructuralmente difiriendo en la posición del grupo hidroxilo. Estos compuestos con estructura fenólica, poseen una mayor actividad antimicrobiana
que los que no la poseen y la presencia y localización del grupo hidroxilo es un factor importante en esta actividad.
Lambert et al., (2001), observaron que el carvacrol y el timol actuaban de forma diferente frente a microorganismos Gram positivos y negativos, pero en otros estudios no se observó la importancia de la posición del grupo hidroxilo, y la capacidad antimicrobiana del timol y carvacrol fue similar.
El carvacrol y el timol aumentan la permeabilidad de la membrana celular desintegrando la membrana externa de las bacterias Gram negativas, liberando los lipolisacáridos (LPS) y aumentando la permeabilidad de la membrana citoplasmática a ATP. Las mediciones de ATP interno y externo revelaron que el ATP celular interno disminuía mientras que no había un aumento proporcional en el exterior celular, de acuerdo a esto se presume que la tasa de síntesis de ATP disminuyo o que la tasa de hidrólisis de ATP incrementó (Alzamora et al., 2000). Burt (2004) observo que las toxinas diarreicas producidas por Bacillus cereus se vieron inhibidas por la presencia de carvacrol en el medio de cultivo y esto puede deberse a que la excreción de la toxina es un proceso activo, y de acuerdo a las dos presunciones anteriores no hay suficiente ATP o fuerza protón motriz (FPM) para exportarla fuera de la célula.
Alternativamente el crecimiento específico da a teorizar que la célula usa la energía (ATP) para mantener las funciones vitales para sostener su viabilidad, dejando a un lado la producción de toxinas (Conner y Beuchat, 1984).
El carvacrol interactúa con la membrana uniéndose a la bicapa de fosfolípidos, provocando la desestabilización de la misma,
aumentando su fluidez e incrementando la permeabilidad pasiva. También, se ha observado el paso de metabolitos celulares a través de la membrana celular. El potencial de membrana también disminuye, debilitando la FPM y el gradiente de pH a través de la membrana. Se concluye por tanto que el carvacrol crea canales a través de la membrana empujando las cadenas de ácidos grasos de los fosfolípidos, permitiendo que los iones abandonen el citoplasma (Burt, 2004).
Por otro lado, el timol se une a las proteínas de membrana de manera hidrofóbica y por puentes de hidrogeno, lo que cambia las características de la permeabilidad de la membrana. Estudios demostraron, que el timol tiene un efecto más inhibitorio en un pH de 5.5 que en uno de 6.5. Al estar en un pH acido la molécula de timol se vuelve más indisociable y por tanto mas hidrofóbica, y por tanto se puede unir mejor a las aéreas hidrofóbicas de las proteínas disolviéndose mejor en la fase lípida lo que puede apoyar la confirmación de la salida de iones intracelulares de K+ por el cambio de la permeabilidad de la membrana (Scheidegger y Payne, 2003).
2.2. Cimeno y γ-terpineno
El precursor biológico del carvacrol es el pcimeno (1-metil-4-(1-metiletil)benceno) que es hidrofóbico y causa turgencia de la membrana citoplasmática en mayor grado que el carvacrol. Esta sustancia no es tan efectiva como antibacterial cuando es usada sola pero combinada con carvacrol, se ha observado sinergismo en B. cereus. Existe una mayor eficiencia de p-cimeno al ser incorporado en la bicapa lipídica de la bacteria ya que facilita el transporte del carvacrol a través de la membrana citoplasmática (Ultée et al., 2002 en Burt, 2004). El γ-terpineno no antagoniza el crecimiento de S. typhimurium mientras el α-
terpineno inhibe de 11 a 25 bacterias (Dorman et al., 2000).
Se ha reportado que compuestos con estructuras fenólicas tienen una alta actividad antimicrobiana seguido por aldehídos, cetonas, alcoholes y otros hidrocarbonos usando métodos de difusión, dilución y contacto gaseoso (Suhr et al., 2000).
(CONACyT, México) por las becas recibidas apoyando los estudios de maestría de A. Rosas Gallo.
Conclusiones
De la revisión realizada se puede concluir que la cantidad de aceite esencial necesaria para ejercer la actividad de los antimicrobianos es la mayoría del tiempo mayor que la cantidad normalmente utilizada como saborizante y se asocia con efectos adversos sensoriales. Además, se recomienda aplicar los aceites esenciales o sus compuestos como parte de un sistema de barrera y de utilizarlo como un componente antimicrobiano, junto con otras técnicas de conservación, por ejemplo, en combinación con la temperatura reducida y la reducción del pH o el uso de una combinación sinérgica de aceites esenciales y sus compuestos, por ejemplo, carvacrol en combinación con p-cimeno (Ultee et al., 2000), lo que permite disminuir sus concentraciones y reducir al mínimo los efectos adversos sensoriales. Es evidente que más estudios son necesarios en las propiedades antimicrobianas de los aceites esenciales y sus compuestos antes de que puedan ser utilizados como conservantes de alimentos.
Referencias
Alzamora, S. M., Tapia, M. S., López-Malo, A. 2000. Minimally Processed Fruits and Vegetables. Aspen Publication, USA.
Baltazar, F. E. 2003. “Mezclas de antimicrobianos naturales y sintéticos para inhibir el crecimiento bacteriano”. Tesis de Maestría. Universidad de las Américas, Puebla, México
Burt S. A. 2004. Essential oils: Their antibacterial properties and potential applications in foods-a review. International Journal of Food Microbiology. 94:223-253.
Burt, S.A. y Reinders R. D.2003.Antibacterial activity of selected plant essential oils agains Escherichia coli 0157:H7. Letters in Applied Microbiology. 36:162-167.
Carrillo, I. M. L. 1999. “Efecto de la actividad de agua, pH y temperatura de incubación en la capacidad antimicótica de mezclas de benzoato de sodio-vainilla”. Tesis de Maestría. Universidad de las Américas, Puebla, México.
Chiasson, F, Borsa J, Ouattara B., Lacroix M. 2004. Radiosensitization of E. coli and S. typhy in ground beef. Journal of Food Protection. 67:1158-1162.
Conner, D.E. y Beuchat , L.R. 1984. “Effects of essential oils form plants on growth of food spoilage yeasts”. Journal of Food Science 49:429-434.
Davidson, P. M. y Branen, A. L. 1997. Antimicrobials in Foods. Marcel Dekker, Inc., New York.
Agradecimientos
A la Universidad de las Américas Puebla y al Consejo Nacional de Ciencia y Tecnología
Dorman, H.J.D. y Deans S.G.2000. Antimicrobials agents from plants: antibacterial activity of plant volatile oils. Journal of Applied Microbiology 88:308-316.
A. Rosas-Gallo et al. / Temas Selectos de
Lambert, R. J., Skandamis P. N., Coote P. J, Nychas G. 2001. A study of the minimum inhibitory concentration and mode of action of oregano essential oil, thymol and carvacrol. Journal of Applied Microbiology. 91:453-462.
Matamoros, L. B. A. 1998. “Actividad antimicrobiana de mezclas sorbato de potasio-vainilla” sobre mohos deteriorativos de frutas”. Tesis de Maestría. Universidad de las Américas, Puebla, México.
Moreno, P. M. M. 2002. “Inhibición de aspergillus flavus y Penicillium digitatum utilizando agentes antimicrobianos naturales y/o sintéticos”. Tesis de Licenciatura. Universidad de las Américas, Puebla, México.
Suhr, K. I. y Nielsen P. V. 2003. Antifungal activity of essential oils evaluated by two different application techniques against rye bread spoilage fungi. Journal of Applied Microbiology. 94:665674.
Giese, J. 1994. Antimicrobials: assuring food safety. Food Technology. 48(6):102-110.
Gould, G. W. y Russell, N. J. 1991. Major foodpoisoning and food-spoilage micro-organisms. En: Food Preservatives. Ed. N. J. Russel and G. W. Gould. Blackie & Son Ltd. Glasgow.
Shelef, L. A. 1983. Antimicrobial effects of spices. Jounal Food Safety. 6:29-44.
Beuchat, L. R. y Golden, D. A. 1989. Antimicrobials occurring naturally in foods. Food Technology. 43(1):134-142.
en Alimentos 5 – 1 (2011): 41 - 50
Farag, R. S., Daw, Z. Y., Hewedi, F. M. y El-Baroty, G. S. A. 1989. Antimicrobial activity of some egyptian spice essential oils. J. Food Protection. 52:665-667.
López-Malo A, Alzamora, S.A, Palou E. 2005. "Naturally Occurring Compounds – Plant Sources". Antimicrobials in Foods, P.M. Davidson, J.N. Sofos, A.L. Branen (Ed.) 3rd Edition. CRC, New York, p. 429-451.
Manou, I., Bouillard, L., Devleeschouwer, M.J., Barel, A.O. 1998. Evaluation of the preservative properties of Thymus vulgaris essential oil in topically applied formulations under a challenge test. Journal of Applied Microbiology. 84, 368–376.
Ultee, A., Slump, R.A., Steging, G., Smid, J., 2000. Antibacterial activity of carvacrol towards Bacillus cereus on rice. Journal of Food Protection. 63 (5), 620–624.
Friedman, M., Henika, P.R., Mandrell, R.E. 2002. Bactericidal activities of plant essential oils and some of their isolated constituents against Campylobacter jejuni, Escherichia coli, Listeria monocytogenes, and Salmonella enterica Journal of Food Protection. 65, 1545–1560.
Scheidegger, K. A. y Payne G.A. 2003. Unlocking the secrets behind secondary metabolism: A review of Aspergillus flavus from pathogenicity to functional genomics. Journal of Toxicology-Toxin Reviews. 22(2-3): 423-459.

Temas Selectos de Ingeniería de Alimentos 5 – 1 (2011): 51 - 63

Extractos de vainilla: una mezcla de componentes químicos de aroma y sabor
T.S. Cid-Pérez* y A. López-Malo
Departamento de Ingeniería Química, Alimentos y Ambiental, Fundación Universidad de las Américas Puebla. Exhacienda Sta. Catarina Mártir S/N, Cholula, Puebla. C.P.72810. México.
Resumen
El sabor a vainilla es el más popular del mundo y se puede utilizar de manera individual o como complemento de otros sabores. La vainillina es el principal componente de las vainas de vainilla al que se le ha atribuido un tercio del sabor y aroma característico. Sin embargo, se han determinado otros componentes que contribuyen al sabor y aroma a vainilla y a los cuales no se les ha dado la misma importancia. Esta revisión propone mostrar los diversos componentes químicos de las vainas de vainilla y sus extractos, así como su participación en el aroma y sabor. La caracterización química reportada en diversas investigaciones muestra que el uso de diferentes técnicas de extracción, separación y elucidación, arroja discrepancias en la identificación de componentes, haciendo difícil la comparación, por lo que se requiere estandarizar y homogenizar técnicas para obtener comparaciones efectivas. No obstante, se puede establecer que la mezcla de componentes volátiles, semivólatiles y no volátiles son los que hacen de los extractos de vainilla una mezcla de aroma y sabor.
Palabras clave: vainilla, vaina, curado, vainillina.
Abstract
Vanilla is the world's most popular flavor, which exotic aroma can act individually or as a complement to other flavors. Vanillin is the main chemical compound in the vanilla pods and that has been attributed a third of the flavor and aroma. However, other components have been identified to which contribute to vanilla’s flavor and aroma that have not been given the same importance. This review proposes show the various chemical constituents of vanilla beans and extracts, and their participation in the aroma and flavor. The chemical characterization reported in several studies demonstrates that the use of different techniques of extraction, separation and elucidation, reveals discrepancies in the identification of vanilla components, making them not comparable, so it is necessary to standardize and homogenize techniques for effective comparisons. However, we can establish that a mixture of volatile, semi-volatile and nonvolatile compounds make vanilla extracts a complex mixture of aromas and flavors.
Keywords: vanilla, pod, curing process, vanillin.
*Programa de Doctorado en Ciencia de Alimentos
Tel: +52 222 229 2126, fax: +52 222 229 2727
Dirección electrónica: teresa.cidpz@udlap.mx
Introducción
La vainilla es una planta nativa de México utilizada como esencia en las bebidas de los dioses que después de la conquista fue conocida alrededor del mundo. Hoy es el saborizante más utilizado en la industria de los alimentos, cuyo sabor y olor característicos son resultado de varios procesos químicos y biológicos, que tienen lugar durante el proceso de curado de las vainas de vainilla (Kouri, 2000; Odoux et al., 2003b).
Existen pocos trabajos que muestren los perfiles químicos de extractos de vainilla debido a que en la mayoría de las investigaciones sólo se determina a los grupos funcionales que se encuentran y no se caracteriza a los componentes químicos específicos de los extractos. Además de no mostrar el proceso o técnica analítica por el cual fue extraído, separado y/o purificado para determinar su dilucidación estructural.
Pese a esto, en las vainas de vainilla se ha reportado ampliamente a la vainillina como el componente químico volátil más importante en la caracterización química, ya que la mayor concentración de ésta se ha relacionado con una mejor calidad de sabor y aroma en las vainas curadas y sus extractos. Sin embargo, existen algunos perfiles químicos que reflejan una gran cantidad de componentes, semivólatiles o no volátiles que otorgan un papel significativo a estos compuestos al impartir a la vainilla o a sus extractos aroma y sabor característico (Sun et al., 2001; John y Jamin, 2004; Rocha et al., 2007; Sinha et al., 2008).
No obstante existen de forma aislada trabajos que reportan componentes volátiles o componentes no volátiles, no así de investigaciones conjuntas donde se muestre un perfil químico amplio (volátiles, no volátiles y semivólatiles), que ayude a
entender como los extractos de vainilla no sólo deben su sabor al componente mayoritario vainillina.
Por tanto, el objetivo de esta revisión es mostrar los diversos componentes químicos de las vainas de vainilla y sus extractos, así como su participación en el aroma y sabor.
Revisión bibliográfica
1. Generalidades de la vainilla
En el siglo XIII el emperador azteca Izcóatl conquistó territorio totonaco obligando a sus habitantes al pago de diversos tributos entre los cuales se encontraba el fruto de la vainilla o flor negra (tlilxochitl). Fue Moctezuma quien invitó a Hernán Cortés a tomar una bebida especial para los dioses denominada chocolatl que se preparaba con semillas de cacao en polvo y vainilla molida que según la leyenda se sirvió con utensilios de oro (Bonfis 1988; Damirón, 2004; FlorzaMartínez et al., 2007). A su partida, los españoles recibieron una gran cantidad de obsequios entre los cuales se encontraba la vainilla, fruto cuyo olor y sabor conquistó al viejo continente (Gatfield, 2002; Damirón, 2004).
Después de la conquista de México, en diversos países de Europa se intentó la producción de vainas de vainilla pero las flores nunca llegaron a producir frutos (vainas), ni siquiera en climas y suelos benefactores para su cultivo. Por esto, durante más de 300 años la producción de vainas de vainilla sólo fue de Papantla México, lo que convirtió a esta ciudad veracruzana en un punto de importancia económica a nivel mundial (Kouri, 2000; Damirón, 2004). Fue hasta 1836 que Charles Morren encontró que las orquídeas no daban frutos en otras partes del mundo debido a
que la polinización natural se daba por avispas de la región (abeja melipona) y/o por el pájaro colibrí, ambos nativos de México (Morris y Mackley, 1999), los cuales no sobreviven en condiciones diferentes a las de las zonas de cultivo. Morren desarrolló un método de polinización artificial, que dio paso a la producción de grandes volúmenes de vainilla (Damirón, 2004), siendo hoy el secreto de la polinización manual el que permite la producción exitosa de vainilla en el mundo.
Desde hace varias décadas México dejó de ser el principal país productor de vainilla, ocupando este lugar Indonesia y Madagascar (FAO, 2008). Sin embargo, México, sigue siendo considerado como el centro clásico e histórico de cultivo y un lugar donde se producen las vainas más finas del mundo (Hernández-Hernández, 2005). La especie Vanilla planifolia, es cultivada principalmente en el clima húmedo y cálido del norte de Veracruz (Papantla, Gutiérrez Zamora, Tecolutla, Martínez de la Torre, Cazones de Herrera, entre otros) en donde se produce cerca del 95% de la vainilla mexicana. Otros estados productores son Puebla y Oaxaca con pocas hectáreas de cultivo (Romeu, 1999; SAGARPA, 2008).
1.1 Botánica
La vainilla es una orquídea trepadora nativa de México del género Vanilla (familia: Orquidaceae), de la cual existen un total de 110 especies. Sin embargo, sólo tres de éstas tienen importancia comercial debido a que producen frutos comestibles: V. planifolia Andrews o V. fragrans (vainilla mexicana o genuina); V. tahitensis JW Moore (vainilla de Tahití) y V pompona (vainilla del oeste de la India) Schiede. Siendo la variedad V. planifolia predominantemente cultivada para la obtención de vainas de vainilla (Bonfis, 1988; Damirón, 2004; Anandaraj et al.,
2005; Mariezcurrena et al., 2008; Sinha et al., 2008).
La planta de vainilla es una herbácea de enredadera que utiliza un gran número de árboles como tutores y sombra, cuyas raíces se desarrollan sin profundizar en el suelo extendiéndose superficialmente a varios metros de distancia (Anónimo, 2006). Sus flores son hermafroditas, siendo el rostellum un órgano especial que hace imposible el contacto del polen con el estigma, lo que causa que la polinización natural deba ser realizada por insectos o por el corte o fisura de este órgano, en el caso de la polinización manual. El fruto es una cápsula verde que al ser cosechado alcanza un promedio de 15-20 cm de largo. Las vainas son firmes, gruesas, de color verde amarillento, sin olor; con semillas muy pequeñas de color obscuro casi negro y globosas con la testa sólida (Bonfis, 1988).
1.2 Proceso de curado en las vainas de vainilla
Originalmente, el fruto maduro de la vainilla no tiene un aroma significativo. Los componentes químicos de aroma y sabor se producen en el proceso de curado también denominado beneficiado de la vainilla. Éste consiste en evitar la respiración de las vainas aplicándoles calor, lo que provoca una deshidratación y una lenta fermentación (Dunphy y Bala, 2010). Los productores y beneficiadores de vainilla consideran que 5 kg de vainilla verde son requeridos para producir 1 kg de vainilla curada (Sachan, 2005).
Los cosechadores mexicanos desarrollaron el proceso de curado de las vainas de vainilla con una duración de cinco a seis meses. Después las colonias francesas de Madagascar y Comoros desarrollaron el proceso llamado Bourbón (Gatfield, 2002). El proceso de curado en México es muy
complejo, multifacético y secuencial. Se lleva a cabo durante un periodo aproximado de 150 días, convirtiendo vainas maduras sin sabor con un contenido de humedad del 80% en vainas de vainilla curadas de color marrón obscuro con un contenido de humedad del 20 al 30% con aroma característico (Dunphy y Bala, 2010). El proceso de curado de las vainas de vainilla en México sigue diversas etapas, las cuales son básicas para la obtención de una vainilla de alta calidad (Roldan et al., 1988; Gillette y Hoffman, 1992; Damirón, 2004; Anandaraj et al., 2005). Este proceso se describe a continuación:
1.- Recepción de la vainilla. Se observan y pesan las vainas de vainilla para determinar su buen estado.
2.- Despezonado. A cada vaina se le desprende el pedúnculo o pezón al que viene adherida y mediante la revisión visual se separan las vainas con algunas fisuras para llevar a cabo el curado de forma independiente.
3.- Enmaletado o encajonado. Se colocan en una manta de 20 a 25 kilogramos de vainas de vainilla y se atan o se colocan en cajones.
4.-Escaldado. Las vainas de vainilla atadas se colocan en un horno permaneciendo de 48 a 60 horas, con una temperatura de 40 a 80° C las primeras 24 horas y las siguientes horas a 65 °C; la capacidad de un horno común es de 300 cajas o maletas.
5.-Primer sudado. Se sacan las vainas de vainilla del horno (vainilla de color marrón) y se cubren con mantas durante 24 a 48 horas para eliminar una gran cantidad de agua.
6.- Asoleado. En esta etapa las vainas de vainilla se tienden en petates o mantas en los patios, aprovechando las horas más intensas
de sol. Después de este tiempo las vainas son colocadas nuevamente en cajas tapándolas con mantas para que suden durante la noche; las asoleadas se seguirán alternando por un mínimo de 15 veces.
7.- Selección. Etapa final en la que se realiza la clasificación de vainas dependiendo de su grosor. Después de esta selección las vainas de vainilla se someten a 3 o 4 asoleadas más con sus respectivas etapas de sudado.
Diversas enzimas están involucradas en la biogénesis del sabor e incluyen a las glucosidasas, oxidasas, sintetasas, metil transferasas, proteasas y fenilalanina amonia liasa. La mayoría de los componentes volátiles se forman de su precursor inmediato o glucósido fenólico al curarse las vainas (Ranadive, 2006). La hidrólisis de varios glucósidos da lugar a componentes del tipo monohidroxifenoles, siendo algunos de los componentes fenólicos oxidados a quinonas aromáticas (Gatfield et al., 2007; Dunphy y Bala, 2010).
Estudios botánicos de las vainas de vainilla revelan que los precursores del sabor se encuentran en el interior de las vainas en la región de la placenta alrededor de las semillas, mientras que las enzimas hidrolíticas y otras enzimas se encuentran principalmente en la pared exterior de la vaina (Sreedhar et al., 2007).
2. Vainilla como saborizante
La vainilla es la segunda especia más cara a nivel mundial, sólo después del azafrán. Sin embargo, es el sabor más popular en el mundo. Tiene un aroma exótico y muy evocador que puede actuar como sabor individual o como complemento de otros sabores como el chocolate (Morris y Mackey, 1999; Soto-Arenas, 2006). La
vainilla como saborizante se puede dividir en tres categorías:
Categoría 1. Corresponde a un extracto de vainilla natural, los alimentos a los que se les adiciona este tipo de extracto son etiquetados como alimentos de vainilla.
Categoría 2. Es un producto de vainillavainillina considerado un saborizante natural-artificial, en el que el componente natural aporta el sabor a vainilla característico. Los productos alimenticios a los que se les adiciona este extracto deben ser etiquetados como alimentos saborizados con vainilla.
Categoría 3. Corresponde a saborizantes de vainillina artificial y los productos que los contienen deben ser etiquetados como alimentos de vainilla saborizados artificialmente (Sachan, 2005).
2.1 Extractos de vainilla natural
Las esencias o extractos de vainilla natural se elaboran picando finamente vainas de vainilla y colocándolas en maceración o infusión en mezclas de alcohol y agua. El proceso generalmente se mantiene a temperatura ambiente (de preferencia frío) para reducir las pérdidas del sabor, aunque algunos fabricantes sugieren que la aplicación de calor favorece la extracción (Jacobs, 1998). Para que un extracto sea comercializado como esencia natural (comercialmente denominado como una gruesa), las vainas utilizadas deben contener un nivel de humedad del 25% y ser maceradas en una solución hidro-alcohólica al 35% en una proporción de 13.35 onzas (380 g) de vainas de vainilla por galón internacional (equivalente a 3.78 L). La presentación inferior de solución hidroalcohólica al 35% debe ser etiquetada como sabor de vainilla, según la legislación estadounidense (Gatfield et al., 2007).
La vainilla concentrada o de dos gruesas es el producto que se obtiene al extraer 26.7 onzas de vainas de vainilla por galón de solución hidro-alcohólica. La combinación de extractos naturales de vainas de vainillas de las regiones de Bourbon-Tahití tiene el nombre de sabor vainilla francesa (Sachan, 2005).
La vainillina es uno de los componentes naturales que da sabor y olor a los extractos de vainilla (Negishi et al., 2009). Recientes investigaciones del perfil químico de los extractos de vainilla la han colocado como el componente principal de las vainas curadas con una concentración del 0.3 a 3%, reconociendo que representa un tercio del sabor y olor de los extractos de vainilla (Shyamala et al., 2007). La vainillina es un compuesto de coloración ligeramente amarilla, volátil, con un olor dulce y carácter cremoso (Tenailleau et al., 2004), que se encuentra acumulado en las vainas verdes de vainilla como un glucósido. Su aroma es liberado sólo después del curado, en el cual el glucósido de la vainillina (glucovainillina) es hidrolizado enzimáticamente por la glucosidasa, liberando a la glucosa y a su aglicona la vainillina (Vega, 1993; Odoux et al., 2003a; Gatfield et al., 2007). Sin embargo, los otros dos tercios de sabor son atribuidos en gran medida a una gran cantidad de componentes no volátiles (glucósidos) o macromoléculas que se encuentran en los extractos de vainilla, los cuales realzan y complementan el sabor de los mismos (Sinha et al., 2008).
Adicionalmente a los extractos y sabores puros de vainilla existen otras opciones para impartir un sabor tipo vainilla.
2.2 Saborizantes tipo vainilla
Un perfil químico del extracto de vainilla natural muestra una mezcla de componentes
químicos que proporcionan aroma y sabor. Sin embargo, la producción industrial se ha limitado a imitar sintéticamente a la vainillina. La síntesis de vainillina es la forma más económica de saborizante artificial y se obtiene principalmente de la lignina (desecho de la industria papelera), del guayacol (derivado del carbón del alquitrán) o del eugenol (Damirón, 2004; Soto-Arenas, 2006).
La etil vainillina es otro componente que se obtiene sintéticamente con el mismo sabor de la vainillina pero con un poder saborizante 2.5 veces mayor, el cual es utilizado comúnmente en los saborizantes de imitación (Gatfield et al., 2007).
Un caso intermedio entre lo natural y artificial es el extracto vainilla-vainillina (líquido o en polvo), el cual es un extracto al que se le ha agregado vainillina sintética (Gatfield, 2002).
3. Composición química de los extractos de vainilla
Las vainas de vainilla contienen una gran cantidad de componentes químicos los cuales le otorgan su sabor y aroma característicos. Siendo los extractos con disolvente los comercialmente utilizados, es reconocido que en el disolvente de extracción se obtendrán componentes volátiles, semivólatiles y una gran cantidad de macromoléculas y componentes no volátiles, lo que hace muy difícil su caracterización química. Sin embargo, algunos de estos extractos se han caracterizado y reportado en la bibliografía. En la Tabla I se muestran los diferentes componentes obtenidos en diversas investigaciones. Se observa que la vainillina se logró identificar en todos los extractos de vainas de vainilla, ya sea como glucósido o aglicona. Mientras que el alcohol vainíllico, p-hidroxibencil alcohol, ácido p-
hidroxibenzoico, p-hidroxibenzaldehído y ácido vainíllico, fueron las únicas coincidencias en tres investigaciones distintas. Por tanto no es posible establecer alguna relación entre técnicas de extracción, separación y purificación con la caracterización química.
Pese a esto, se pueden clasificar como componentes volátiles a todos aquellos que se separaron de los diversos extractos de vainilla mediante cromatografía de gases: vainillina, p-hidroxibencil alcohol, phidroxibenzaldehído, alcohol vainíllico, ácido p-hidroxibenzoico, ácido vainíllico, alcohol anísico, ácido anísico, etil hexanoato, etil nonanoato, etil decanoato, pmetoxibenzaldehído, entre otros. A estos compuestos se les atribuyen totalmente las propiedades de aroma debido a su volatilidad, además del sabor que otorgan a los extractos de vainilla (Kaunzinger et al., 1997; Sostaric et al., 2000).
En la técnica de microextracción en fase sólida se encuentran componentes químicos volátiles y semivólatiles, los cuales se obtienen por espacio de cabeza. Estos componentes químicos pueden ser separados mediante cromatografía líquida o de gases, siendo los componentes semivólatiles de las vainas de vainilla a los que se les ha atribuido la menor contribución al aroma y sabor (Sostaric et al., 2000).
Como componentes no volátiles se tienen a todos aquellos que presentan elevado peso molecular y/o estructuras altamente polares como glucosa, sacarosa, píranos, glucósidos y otros compuestos separados o fraccionados por cromatografía líquida o cromatografía en columna (Palama et al., 2009; Schwartz Hofmann, 2009) y cuyas estructuras fueron determinadas por un espectrómetro de masas (estructura conocida) y/o resonancia magnética nuclear (estructura desconocida).
A estos componentes se les ha atribuido la
Tabla I. Caracterización química de extractos de vainilla, con diferentes métodos de separación y elucidación estructura
Especie CAS Compuesto Autor Método Estructura
V. planifolia
V. pompona
V. planifolia
V. planifolia
V. tahitensis
V.pompona V. planifolia
V. planifolia
V. tahitensis
V. tahitensis
V. tahitensis
V. tahitensis
V. pompona
V. planifolia
V. planifolia
V. planifolia
V. pompona
V. planifolia
623-05-2 p-hidroxibencil alcohol
123-08-0 p- hidroxibenzaldehÍdo
121-33-5 Vainillina
498-00-0 Alcohol vainíllico
V. planifolia 139-85-5 3,4Dihidroxibenzencarbonal
V. planifolia
V. tahitensis
V. planifolia
V. planifolia
V.pompona V. planifolia
99-96-7 Ácido phidroxibenzoico
Kaunzinger et al., 1997
Shymala et al., 2007
Palama et al., 2009
Kaunzinger et al., 1997
Kaunzinger et al., 1997
Shymala et al., 2007
Palama et al., 2009
Kaunzinger et al., 1997
Kaunzinger et al., 1997
Sostaric et al., 2000
Sostaric et al., 2000
Sostaric et al., 2000
Shymala et al., 2007
Schwarz et al., 2009
Palama et al., 2009
Kaunzinger et al., 1997
Shymala et al., 2007
Palama et al., 2009
CG-EMRI CLAR CL-EM/RMN
CG- EMRI CG- EMRI CLAR CL-EM/RMN
CG-EMRI CG-EMRI MEFS/CG-EM MEFS/CG-EM MEFS/CG-EM CLAR CL-EM/RMN CL-EM/RMN
CG-EMRI CLAR CL-EM/RMN
Palama et al., 2009 CL-EM/RMN
Kaunzinger et al., 1997
Kaunzinger et al.,1997
Palama et al., 2009
121-34-6 Ácido vainíllico Kaunzinger et al.,1997
Shymala et al., 2007
Palama et al., 2009
V. tahitensis 105-13-5 Alcohol anísico Kaunzinger et al., 1997
V. tahitensis
V. tahitensis
V. tahitensis
V. tahitensis
V. tahitensis
V. tahitensis
V. tahitensis
V. tahitensis
V. tahitensis
V. tahitensis
V. tahitensis
100-09-4 Ácido anísico
123-66-0 Etil hexanoato
120-58-1 1,3-Benzodioxole, 5-(1-propenil)
123-29-5 Etil nonanoato
Kaunzinger et al., 1997
Sostaric et al., 2000
Sostaric et al., 2000
Sostaric et al., 2000
Sostaric et al., 2000
Sostaric et al., 2000
Sostaric et al., 2000
Sostaric et al., 2000
Sostaric et al., 2000
Sostaric et al., 2000
Sostaric et al., 2000
CG-EMRI CG-EMRI CL-EM/RMN
CG-EMRI CLAR CL-EM/RMN
CG-EMRI
CG-EMRI MEFS/CG-EM
MEFS/CG-EM MEFS/CG-EM MEFS/CG-EM
MEFS/CG-EM
MEFS/CG-EM MEFS/CG-EM
MEFS/CG-EM MEFS/CG-EM MEFS/CG-EM












Cont…Tabla I. Caracterización química de extractos de vainilla, con diferentes métodos de separación y elucidación estructura.
Especie CAS Compuesto Autor Método Estructura
V. tahitensis
V. tahitensis
V. tahitensis
V. tahitensis
V. tahitensis
V. tahitensis
103-26-4 Ácido cinámico
110-38-3 etil decanoato
V. tahitensis 123-11-5 p-metoxi benzaldehído
V. planifolia
V. planifolia
494-08-6 Glucovainillina
V. planifolia 5-(4-hidroxibenzil) vainillina
V. planifolia Americanin A
V. planifolia 4-(4hidroxibencil)-2metoxifenol
V. planifolia 4-hidroxi-3-(4hidroxi-3metoxibencil)-5metoxibenzaldehíd o
V. planifolia (1-O-vanillil)-(6O-feruloil)-β-Dglucopiranosido
Sostaric et al., 2000
Sostaric et al., 2000
Sostaric et al., 2000
Sostaric et al., 2000
Sostaric et al., 2000
Sostaric et al., 2000
Sostaric et al., 2000
Schwartz y Hofmann, 2009
Palama et al., 2009
Schwartz y Hofmann, 2009
Schwartz y Hofmann, 2009
Schwartz y Hofmann, 2009
MEFS/CG-EM
MEFS/CG-EM
MEFS/CG-EM
MEFS/CG-EM
MEFS/CG-EM
MEFS/CG-EM
MEFS/CG-EM
CL-EM/RMN
CL-EM/RMN
CL-EM/RMN
CL-EM/RMN
CL-EM/RMN
Schwartz y Hofmann, 2009 CL-EM/RMN








Schwartz y Hofmann, 2009 CL-EM/RMN
V. planifolia Divanillin Schwartz y Hofmann, 2009 CL-EM/RMN
V. planifolia 4,6-dihidroxi-3,5dimetoxi-[1,1bifenil]-3carboxaldehído
V. planifolia phidroxibenzaldehíd o glucósido
Schwartz y Hofmann, 2009 CL-EM/RMN
Palama et al., 2009
V. planifolia 7-50-1 Sacarosa Palama et al., 2009
V. planifolia 50-99-7 Glucosa
Palama et al., 2009
CL-EM/RMN
CL-EM/RMN
CL-EM/RMN






Cont…Tabla I. Caracterización química de extractos de vainilla, con diferentes métodos de separación y elucidación estructura.
Especie CAS Compuesto Autor Método Estructura
V. planifolia 636-61-3 Acido málico
V. planifolia 3562-74-1 Ácido homocítrico
V. planifolia
V. planifolia
bis[4- Dglucopiranosiloxi)benzil]-2isopropiltartrato
bis[4-( Dglucopiranosiloxi)bencil]-2-(2-butil) tartrato
Palama et al., 2009
CL-EM/RMN
Palama et al., 2009 CL-EM/RMN
Palama et al., 2009 CL-EM/RMN
Palama et al., 2009
CL-EM/RMN


MEFS/CG-EM: Microextracción en fase sólida y cromatografía de gases acoplada a un espectrómetro de masas.
RMN: Resonancia magnética nuclear.
CG-EMRI: Cromatógrafo de gases acoplado a un espectrómetro de masas de relación isotópica
CLAR: Cromatografía líquida de alta resolución
CL-EM/RMN: Cromatografía líquida acoplada a un espectrómetro de masas y resonancia.
mayor aportación de sabor en las vainas y extractos de vainilla.
A continuación se hace un resumen de las investigaciones reportadas en la Tabla I, respecto a la vainilla utilizada para explicar las diferencias en los perfiles químicos, ya que estas discrepancias se deben al disolvente o mezcla de disolventes utilizados, tipo de extracción, técnica de separación, así como el equipo espectroscópico utilizado en la caracterización de las vainas de vainilla. En la siguiente sinopsis se podrán observar éstas:
Se han identificado como componentes químicos de la V. pompona nativa de la India (Shymala et al., 2007) a la: vainillina, ácido vainíllico, alcohol vainíllico, phidroxibenzaldehído y p‐hidroxibencil alcohol en extractos alcohólicos. El perfil químico se obtuvo por la comparación de los
tiempos de retención de estándares y extractos en un cromatógrafo de líquidos de alta resolución.
La vainilla V. tahitensis fue evaluada por Sostaric et al. (2000) para determinar los perfiles químicos y componentes volátiles de extractos etanólicos de vainas cultivadas en diferentes regiones (Indonesia, Bourbon y Tahití) por cromatografía de gases acoplada a un espectrómetro de masas (CG-EM). Los componentes fueron extraídos mediante microextracción en fase sólida, e inyectados directamente al cromatógrafo. Para el extracto de Tahití se logró caracterizar etil hexanoato, 5-propenil-1-1,3-benzodioxole, etil nonanoato, ácido metiléster 2propenoico, etil decanoato, vainillina, pmetoxibenzaldehído y ácido anísico, Mientras que para los extractos de Indonesia y Bourbon se logró determinar sólo a los seis primeros componentes.
De manera similar Kaunzinger et al (1997) analizaron diversos extractos alcohólicos de V. tahitensis de dos diferentes cosechas para determinar los perfiles químicos de autenticidad de la vainilla de esta especie (a través de la caracterización química de componentes). Se utilizó un cromatógrafo de gases adaptado a un espectrómetro de masas de relación isotópica (CG-EMRI), determinando a phidroxibenzaldehído, vainillina, alcohol anísico, ácido anísico y ácido phidroxibenzoico como los componentes mayoritarios. De la misma forma se determinó la autenticidad de la vainilla de la especie V. planifolia encontrando al phidroxibencil alcohol, phidroxibenzaldehído, vainillina, alcohol vainíllico, ácido p-hidroxibenzoico y ácido vainíllico como los componentes de esta especie (Kaunzinger et al.,1997).
Palama et al. (2009) determinaron los cambios que ocurren en las diferentes etapas de maduración de las vainas verdes de V. planifolia, en extractos metanol-agua (concentración 1:1), logrando identificar a los metabolitos: p-hidroxibenzaldehído glucósido, glucovainillina, vainillina, phidroxibenzaldehído, sacarosa, glucosa, ácido málico, bis[4-(Dglucopiranosiloxi)-benzil]-2isopropiltartrato, bis[4-(-Dglucopiranosiloxi)-benzil]-2-(2-butil) tartrato y ácido homocítrico, mediante resonancia magnética nuclear (RMN). Con ayuda de un cromatógrafo de líquidos acoplado a un espectrómetro de masas (CL-EM) consiguieron caracterizar a los componentes minoritarios de las vainas verdes entre los que se encontraron: p-hidroxobencil alcohol, protocatechualdehído, alcohol vainíllico, ácido p-hidroxibenzoico y ácido vainíllico.
Por otro lado Schwartz y Hofmann (2009) identificaron moléculas activas con
propiedades organolépticas en vainas curadas de V. planifolia. La obtención de componentes activos se realizó con extracciones sucesivas de disolventes (heptano, acetato de etilo y agua), los cuales fueron eliminados a vacío para posteriormente realizar el análisis de perfiles de sabor en soluciones acuosas. Se demostró que la fracción de acetato de etilo tiene una evaluación de sabor superior a las otras dos fracciones, por lo que se llevó a cabo la separación de sus componentes químicos (fracción de acetato) mediante cromatografía líquida preparativa. Se obtuvieron 29 subfracciones que fueron evaluadas por el panel de jueces para determinar el factor de dilución y el impacto del sabor. A las subfracciones con mayor potencial de sabor se les realizaron comparaciones espectroscópicas (CL-EM, RMN) para determinar las estructuras químicas. Estos autores encontraron los siguientes componentes en las subfracciones: 4-(4hidroxibencil)-2-metoxifenol, 4-hidroxi-3(4-hidroxi-3-metoxibencil)-5metoxibenzaldehído, (1-O-vanilloil)-(6-Oferuloil)-β-D-glucopiranosido, americanin A, 4´,6´-dihidroxi-3´,5-dimetoxi-[1,1´-bifenil]3-carboxaldehído, 5-(4-hidroxibencil), glucovainillina, divainillina y vainilla. De las primeras cinco estructuras no se tenía información de su presencia en las vainas de vainilla.
Si bien es reconocido que la mayoría de los componentes volátiles (carbonilos, alcoholes aromáticos, ácidos aromáticos, ésteres aromáticos, alcoholes alifáticos, ácidos, ésteres, lactonas, hidrocarburos aromáticos, terpenoides, hidrocarburos alifáticos y heterocíclicos) que fueron separados y caracterizados mediante cromatografía de gases-espectrómetro de masas son responsables de la esencia de las vainas de vainilla, existen también diversas macromoléculas y metabolitos no volátiles (separados y caracterizados mediante
cromatografía de líquidos-espectrómetro de masas) que contribuyen al olor y sobre todo al sabor. Tal es el caso de compuestos como taninos, polifenoles, resinas, ácidos grasos, aminoácidos libres, ácido caféico, minerales, proteínas, ligninas, entre otros (Sinha et al., 2008; Dunphy y Bala, 2010). Son todos estos componentes químicos los que producen un delicado y delicioso aroma a especias de maderas dulces y balsámicas (Ranadive, 2006).
(CONACyT, México) por el financiamiento recibido para la realización de este trabajo.
Referencias
Anandaraj, M., Rema, J., Sasikumar, B. y SuseelaBhai. 2005. Vanilla extension Pamphlet. PrinterCastle, Kochi. India. 1-11.
Anónimo. Proyecto Chinantla. 2006. Vainilla. Productos forestales no maderables de la Chinantla. 1. (4):1-2. Disponible en: http://grupomesofilo.org/folleto-no-maderables.pdf
Conclusión
Se han mostrado los diversos componentes químicos en los extractos de vainas de vainilla, estableciendo que el perfil químico obtenido depende de la especie o variedad de vainilla utilizada, método de extracción y/o disolventes empleados, así como del equipo analítico con el que se lleva a cabo la caracterización química. Se concluye que el olor y sabor de los extractos de vainilla depende de una mezcla de componentes volátiles, semivólatiles y no volátiles que hace del extracto de vainilla una esencia exótica que sigue conquistando al mundo. Sin embargo, en términos de caracterización, son necesarias más investigaciones que aporten información sobre la composición cualitativa y cuantitativa de las fracciones volátiles y no volátiles en vainas curadas de vainilla y sus extractos. También se detectó la necesidad de estandarizar técnicas de separación y caracterización con la finalidad de establecer perfiles de comparación entre diferentes extractos y variedades de vainilla.
Agradecimientos
A la Universidad de las Américas Puebla y al Consejo Nacional de Ciencia y Tecnología
Fecha de consulta: 15 de marzo del 2011.
Bonfis, C. 1988. Vainilla. Revista de revisión Facultad de Ciencias UNAM. 51: 1-2.
Damirón, R. 2004. La vainilla y su cultivo. Dirección General de Agricultura del Estado de Veracruz. Disponible en: http://www.concitver.com/archivosenpdf/El%20C ultivo%20de%20la%20Vainilla.pdf.
Fecha de consulta: 15 de marzo del 2011.
Dunphy, P. y Bala, K. 2010. Review: A flavor of vanilla. Perfumer & Flavor.35:1-8.
FAO. 2008. Consulta de bases de datos de producción mundial y comercio internacional de vainilla.
Disponible en: http://faostat.fao.org/site/339/default.aspx . Fecha de consulta: 12 de abril del 2011.
Florza-Martínez, P., López-Herrera, M., HernándezFuentes, A., Olmedo-Pérez, G. y DomínguezBarradas, C. 2007. Efecto del tipo de tutor sobre el contenido de vainillina y clorofila en vainas de vainilla (Vanilla planifolia Andrews) en Tuxpan, Veracruz, México. Revista Agrícola. 7: 228-236.
Gatfield, I. 2002. Ingredientes al día: La biotecnología de los aromas. Industria Alimentaria 21:50-58. www.industriaalimentaria.
Fecha de consulta: 13 de marzo del 2011.
Gatfield, I., Hilmer, J., Weber, B., Hammerschmidt, F. Reib, I., Poutot, G. y Bertram, G. 2007. Chemical and Biochemical changes occurring during the traditional Madagascar vanilla curing process. Perfumer & Flavor. 32:1-8.
Gillette, M. y Hoffman, P. 1992. Vanilla extract. Encyclopedia of Food Science and Technology Wiley New York. 4: 2641-2657.
Hernández-Hernández, J. 2005. Vanilla production in México. III Congreso Internacional de Vainilla, 15 y 16 de noviembre. Boca del Río, Veracruz, México. Disponible en: http://www.baktoflavors.com/vanilla2005/Hernan dez_abstract.html
Fecha de consulta: 14 de marzo del 2011.
Jacobs, M. 1998. The Chemical Analysis of Foods and Food Products. Tercera edición. Van Nostrand Reinhold. New York. 22-24 p.
John, T.V., y Jamin, E. 2004. Chemical Investigation and Authenticity of Indian Vanilla beans. Journal of Agricultural and Food Chemistry. 52: 76447650.
Kaunzinger, A., Juckelka, D. y Mosandl, A. 1997. Progress in the Authenticity Assessment of Vanilla. 1. Initiation of Authenticity Profiles. Journal of Agricultural and Food Chemistry.45:1752-1757.
Kouri, E. 2000. La vainilla de Papantla: Agricultura, comercio y sociedad rural en el siglo XIX. Signos Históricos. II. (3):105-130.
Mariezcurrena, M., Zavaleta, H., Waliszewski, K. y Sánchez, V. 2008. The effect of killing conditions on the structural changes in vanilla (Vanilla planifolia, Andrews) pods during the curing process. International Journal of Food Science and Technology. 43: 1452-1457.
Morris, S. y Mackley L. 1999. La gran enciclopedia de las especias. Ediciones Hymsa-Grupo editorial Edipresse. España. 45 p.
Negishi, O., Sugiura, K. y Negishi, Y. 2009. Biosíntesis of Vanillin via Ferulic Acid in Vanilla planifora Journal of Agricultural and Food Chemistry. 57:9956-9961.
Odoux , E., Chauwing, A. y Brillouet, J. 2003a. Purification and Characterization of Vanilla Bean (Vanilla planiflora Andrew) -D-Glucosidasa. Journal of Agricultural and Food Chemistry 51:3168-3173.
Odoux, E., Escoute, J., Verdeil, J. y Brillouet, J. M. 2003b. Localization of β-D-glucosidase activity and glucovanillin in vanilla bean (Vanilla planifolia Andrews). Annals of Applied Biology. 92:437–444.
Palama, T., Khatib, A., Choi, Y., Payet, B., Fock, I., Verpoorte, R. y Kodja, H. 2009. Metabolic Changes in Different Developmental Stages of Vanilla planifolia Pods. Journal of Agricultural and Food Chemistry. 57: 7651-7658.
Ranadive, A. 2006. Chemistry and Biochemistry of Vanilla flavor. Perfumer & Flavor. 31: 38-46.
Rocha, L., Rodríguez, E., y Bezerra. 2007. Análisis multivariado de perfiles obtenidos por cromatografía líquida de alta eficacia para la discriminación de especies vegetales de Phyllantus. Productos naturales. 4:11-14.
Roldán, I., Eleuterio, C., Mata, J., Lara, M. y Paz, J. 1988. El cultivo de la vainilla en Usila, Oaxaca. Organización y Autogestión Campesina. Dirección General de Culturas Populares, SEP. México. 63-65 p.
Romeu, E. 1999. La vainilla: de Papantla a Papantla, el regreso de un cultivo. http:// www.Conabio.gob.mx/biodiversitas/Vainilla Fecha de consulta: 15 de marzo del 2011.
Sachan, D. 2005. Vanilla and its potential in India. Brief on New Publications.17: 1-4.
SAGARPA. 2008. Consulta de Indicadores de Producción Nacional de Vainilla Beneficiada. Disponible en: http://siap.sagarpa.gob.mx /vainilla. Fecha de consulta: 12 de abril del 2011.
Schwartz, B. y Hofmann, T. 2009. Identification of Novel Orosensory Active Molecules in Cured Vanilla Beans (Vanilla planifolia). Journal of Agricultural and Food Chemistry. 57: 3729-3737.
Shyamala, B., Madhava, M., Sulochanamma, G. y Srinivas, P. 2007. Studies on the Antioxidant activities of natural Vanilla Extract and Its constituent compounds through in Vitro models. Journal of Agricultural and Food Chemistry. 55: 7738-7743.
Sinha, A., Sharma, U. K. y Sharma N. 2008. A comprehensive review on vanilla flavor: Extraction, isolation and quantification of vanillin and others constituents. International Journal of Food Sciences and Nutrition. 59(14): 299-326.
Sostaric, T., Boyce, M. C. y Spickett, E. 2000. Analysis of the volatile Components in vanilla extracts and Flavoring by Solid-Phase Microextraction and Gas Chromatography. Journal of Agricultural and Food Chemistry.
48:5802-580.
Soto-Arenas, A. 2006. La vainilla: retos y perspectivas de su cultivo. CONABIO. Biodiversitas. 66: 1-9.
Sreedhar, R., Roohie, K., Venkatachalam, L., Narayan, M. y Bhagyalaksmi, N. 2007. Specific Pretreatments Reduce Curing Period of Vanilla (Vanilla planifolia) Beans. Journal of Agricultural and Food Chemistry. 55: 2947-2955.
Sun, R., Sacalis, J., Chin C. y Still C. 2001. Bioactive Aromatic Compounds from Leaves and Stems of
Vanilla fragrans. Journal of Agricultural and Food Chemistry. 49: 5161-5164.
Tenailleau, E. J., Lancelin, P., Robins, R. J. y Akoka S. 2004. Authentication of the origin of vanillin using Quantitative Natural Abundance 13 C NMR Journal of Agricultural and Food Chemistry 52:7782-7787.
Vega, J. 1993. Transformación de materiales lígnicos a compuestos de alto valor agregado. Seminario de San José, Laboratorio de Polímeros, Universidad de Costa Rica. 1-11 p.

Contenido
Temas Selectos de Ingeniería de Alimentos Vol. 5 / No. 1

Volumen 5 / No. 1 Ene – Mayo 2011
Artículos de Revisión
Cambios en características funcionales de productos alimenticios tratados por homogeneización a ultra alta presión
G. G. Amador Espejo* y H. Ruiz-Espinosa ………………………………………………………...
Nanotecnología en alimentos
G. Soto-Chilaca* y A. López-Malo ………………………………………………………...………..
Procesos avanzados de oxidación y su aplicación en alimentos
V. Aurioles-López*, A. López-Malo y E. R. Bandala ……………………………………...………
Mostaza: características químicas, botánicas y sus aplicaciones en el área de alimentos
B. Mejía-Garibay*, A. López-Malo y J.A. Guerrero-Beltrán
Actividad antimicrobiana de aceite esencial de tomillo (Thymus vulgaris)
A. Rosas-Gallo* y A. López-Malo
Extractos de vainilla: una mezcla de componentes químicos de aroma y sabor
T.S. Cid-Pérez* y A. López-Malo ………………………………………………………………….

Departamento de Ingeniería Química, Alimentos y Ambiental Derechos Reservados 2010
